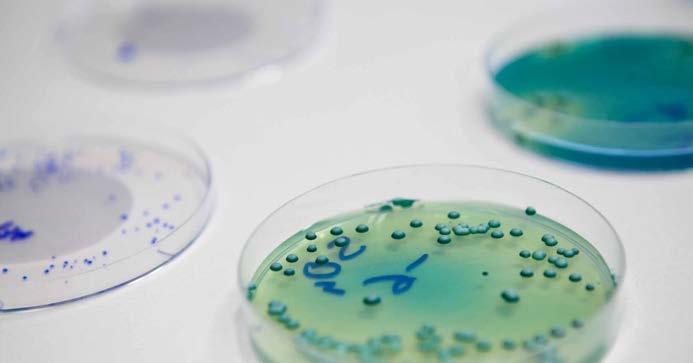

SEMINARI INCONTRO CON LO CHAMPAGNE IN STAGIONE FLAVESCENZA DORATA TUTELA IL PUNTO SUL CASO PROŠEK LUGLIO /2022 magazine Anno 23Numero IVLuglio 2022Periodico TrimestralePoste Italiane SpASpedizione in Abbonamento Postale70%NE/T VContiene I.P. Enoturismo: “A Cena col Paesaggio” Tre serate in abbinamento alle bollicine del Prosecco Superiore
Coesione, collaborazione e compartecipazione con tutti gli attori del territorio, e con le istituzioni: queste le chiavi del primo anno del nuovo Consiglio
Un anno di lavoro insieme
È trascorso ormai un anno dalla mia elezione a presidente del Consorzio di Tutela del Conegliano Valdobbiadene Prosecco DOCG. Un anno di lavoro in tenso e di sviluppo, per il Consorzio e tutta la Denominazione. Sin dai primi giorni del mio mandato sono stati chiari l’ampiezza e la consistenza del lavoro consor tile, la cui rilevanza si declina in molte direzioni: verso i soci, verso il territorio, verso le istituzioni locali e nazionali e verso tutti gli appassionati di vino in ge nerale e di Conegliano Valdobbiadene Prosecco Superiore DOCG in particolare.

Per assolvere ai tanti compiti a cui è chiamato il Consorzio di Tutela è stato urgente nominare un direttore che, insieme al nuovo Consiglio di ammini strazione, abbiamo individuato nella figura del dottor Diego Tomasi, ricercatore e studioso stimato nel settore e profondo conoscitore della nostra Denomi nazione. Grazie al suo ingresso in Consorzio ha preso avvio il consolidamento dell’ufficio tecnico, strumento fondamentale per tutti i viticoltori, in particolare in questi mesi in cui stiamo affrontando la grave minaccia della flavescenza do rata. Con l’obiettivo di monitorare il tema della flavescenza è stato istituito un tavolo di lavoro che vede impegnato il Consorzio in prima linea e a cui partecipa no anche associazioni di categoria con cui teniamo relazioni proficue.
Il Consorzio di Tutela, oltre ai temi tecnici e agronomici, consolida quoti dianamente un dialogo vivace con tutti gli attori del territorio. Da questa volon tà di relazione costante si è rafforzata una sinergia efficace con la Strada del Prosecco e vini dei Colli di Conegliano Valdobbiadene che ha visto una riuscita collaborazione nell’iniziativa Conegliano Valdobbiadene Experience, e in parti colare con gli appuntamenti “A cena con il paesaggio” curati dal Consorzio.
Ma importanti collaborazioni sono in atto anche sul fronte della valoriz zazione del paesaggio e del territorio da un punto di vista enoturistico; in questa direzione stiamo lavorando a stretto contatto in particolare con l’Associazione per il Patrimonio UNESCO delle Colline del Prosecco di Conegliano e Valdobbia dene. Mentre sul fronte della valorizzazione del prodotto sono attivi i rapporti con la Primavera del Prosecco e la Confraternita di Valdobbiadene. Per garanti re la qualità del prodotto e la tutela del paesaggio è stato rinnovato quest’anno il blocco dei nuovi impianti, perché la superficie vitata rimanga delle dimensioni attuali, il che garantisce che le zone vitate siano le migliori per ottenere uva ec cellente, e che si conservi quel paesaggio a mosaico che alterna vigneti a bosco, una delle caratteristiche che ha portato al riconoscimento UNESCO.

3 BENVENUTI
La ricchezza culturale e il fermento che contraddistinguono la nostra Denominazione è un patrimonio comune che va sostenuto e in quanto protago nisti del territorio sentiamo la responsabilità di supportare attività come quel la di Fondazione Zanzotto che promuove il pensiero e le parole dello scrittore, voce inimitabile delle nostre colline. Ma il nostro territorio deve essere di ispi razione anche agli autori contemporanei per questo abbiamo deciso di coinvol gere direttamente cinque autori finalisti di Premio Campiello Giovani per far loro respirare la vita tra i filari e in cantina e dare loro la possibilità di tradurre questa ispirazione in una prosa originale, testimone della cultura umana delle nostre colline.
Il nostro è un territorio che parla a più voci e in questo anno abbiamo cercato di non trascurare l’ascolto di nessuna di queste. Ad esempio, partecipia mo attivamente al tavolo proposto dalla Diocesi di Belluno e Vittorio Veneto per la tutela ambientale del territorio e siamo in dialogo costante con le associa zioni di categoria locali e nazionali, in particolare queste ultime sono diventate nostre alleate nella battaglia di respiro europeo contro Prošek, naturalmente insieme agli altri due Consorzi del mondo Prosecco e alle istituzioni locali e na zionali.

La stagione 2021/2022 ha rappresentato un anno di ripresa ed anche le attività del Consorzio, in Italia e all’estero, sono ripartite con successo. Vinitaly come Prowein hanno dimostrato che c’è desiderio forte di rimettersi in gioco e il Conegliano Valdobbiadene Prosecco Superiore DOCG ha dato prova di saper competere sui mercati con l’autorevolezza di un prodotto solido e di valore.
Durante quest’anno ho avuto modo di partecipare in prima persona a interessanti momenti di confronto di alto livello istituzionale, in cui siamo sta ti chiamati per rappresentare una parte produttiva importante dell’economia italiana. Penso con orgoglio alla nostra partecipazione al Convegno proposto dal Ministero degli Esteri sulla diffusione e promozione della lingua italiana all’estero. Al tavolo erano presenti esponenti autorevoli dei comparti economici più performanti del Paese e il Consorzio ha rappresentato, oltre che il nostro territorio, la capacità del mondo del vino di esportare non solo un saper fare enologico ma anche la cultura dell’Italian Style che ci guida ogni giorno. Inoltre, il nostro Consorzio è stato scelto per intervenire ad un convegno organizzato dalla Banca Monte Paschi di Siena insieme alla redazione economica del Cor riere della Sera per sviscerare le opportunità offerte dal PNRR e i vantaggi che questo momento storico ci chiede di individuare per ogni settore.
Il Consorzio di Tutela del Conegliano Valdobbiadene Prosecco DOCG non rappresenta unicamente una grande realtà enologica, ma una comunità coesa e caparbia che dimostra ogni giorno quanto sia importante lavorare all’unisono per raggiungere risultati rilevanti a qualsiasi livello, sia che si tratti della bat taglia contro la flavescenza dorata oppure quella contro chi minaccia il nostro brand. Il Consorzio di Tutela del Conegliano Valdobbiadene Prosecco DOCG con tinuerà nel solco delle azioni intraprese a rappresentare l’anima e l’impegno di ciascun viticoltore e produttore.

5
VIA ETTORE MAJORANA 1051 | 31053 PIEVE DI SOLIGO | TREVIS O T. +39 338 6287050 | MAIL: INFO@M2XTRIVENETO.IT Soluzioni
esperienza
i vini
IL NOSTRO OBIETTIVO È CRESCERE INSIEME A VO I
TRIVENETO
ed
per
del nostro territorio.
_dalla parte di chi dà valore alla terra_
ISSUE 01 LUGLIO /2022
contenuti
COLOPHON


Proprietario
CONSORZIO TUTELA VINO CONEGLIANO VALDOBBIADENE PROSECCO Piazza Libertà 7 - Località Solighetto 31053 Pieve di Soligo (TV) t/ +39 0438 83028 f/ +39 0438 842700 info@prosecco.it www.prosecco.it
Presidente Elvira Bortolomiol
Direttore responsabile Paolo Colombo
Redattori Marta Battistella Giorgia Dotto Giulia Pussini Renata Toninato
Editore e concessionaria pubblicitaria EDIMARCA Sas Strada Comunale delle Corti 56 31100 TREVISO t/ +39 0422 305764 redazione@edimarca.it Iscrizione ROC 14021
Immagini fotografiche Archivio Consorzio
In copertina Fotografia di Arcangelo Piai Progetto grafico mimicocodesign Stampa MARCA PRINT snc Via Dell’Arma di Cavalleria 4 31055 Quinto di Treviso (TV)
TUTELA
CASO “PROŠEK”: A DIFESA DEL TERRITORI 0 9 Il mondo Prosecco minacciato dalla richiesta croata
EVENTI
A CENA COL PAESAGGIO 1 5
Il Consorzio firma tre straordinarie serate nell’ambito della Conegliano Valdobbiadene Experience
INCONTRI
AUMENTI DEI COSTI E SCENARI FUTURI 21
Un incontro per tracciare le linee future e strategiche per uscire dalla crisi
DEGUSTAZIONI IN REDAZIONE 2 5 Tre giornate milanesi dedicate ad incontri con la stampa Condé Nast, RCS Cairo e Stile Italia Edizioni
SEMINARI
IL CONSORZIO INCONTRA LO CHAMPAGNE 27 ParallelismI tra I due vini icona dell’enologia mondiale

SPORT
GIOVANI CICLISTI SULLE COLLINE 29 Meeting Nazionale Giovanissimi 2022
7
R&D PER LE AZIENDE DEL SETTORE VITICOLO ENOLOGICO SERVIZIO NAZIONALE RITIRO CAMPIONI LABORATORIO ACCREDITATO ACCREDIA RILASCIO CERTIFICATI PER ESPORTAZIONE VINI ANALISI A SUPPORTO DEL PROCESSO DI VINIFICAZIONE CONSULENZA ENOLOGICA ANALISI SPECIALISTICHE Studio Michelet - Via Vital, 96 - 31015 Conegliano (TV) T 0438 415202 info@studiomichelet.com www.studiomichelet.com
31 In visita al territorio ospiti provenienti da Regno Unito, USA,
Australia IWSC: PREMI PER LA DOCG 35 DIGITAL SOCIAL IN USA 3 6 RUBRICHE DICONO DI NOI 3 8 MAPPA DELLA ZONA DOCG 42 L’ALVEARE, UNA CENTRALINA AMBIENTALE PERFETTA 57 LA PRIMA EDIZIONE DI “VITE IN CAMPO” 61 LIFE-ATENA: UN TRATTORE IBRIDO PER LA DENOMINAZIONE 65 LA FLAVESCENZA DORATA DELLA VITE 69 in stagione TECNICHE E SOLUZIONI VITIVINICOLE Nessun albero è stato abbattuto per la stampa di questo giornale. Stampato su carta riciclata 100%. Cyclus Print by Dalum A/S ANNO 24 - N.2 - Luglio 2022 Periodico Trimestrale Registrazione Tribunale di Treviso n. 1081 del 25.01.1999 Poste Italiane SpA Spedizione in Abbonamento Postale 70% - NE/TV
PROMOZIONE INTERNAZIONALE INCONTRI INTERNAZIONALI
Norvegia e

9 Conegliano Valdobbiadene luglio /2022 TUTELA CASO “PROŠEK”: A DIFESA DEL TERRITORIO IL MONDO PROSECCO MINACCIATO DALLA RICHIESTA CROATA DI MENZIONE DEL VINO PROŠEK
foto di Arcangelo Piai
Esploso nel novembre scorso – anche se nella realtà partito quasi un decennio prima, con la richiesta di menzione croata all’Ue – quello del caso Prošek può erroneamente apparire una semplice questione di “naming”, ovvero di confusione di nomi simili. Oppure di “italian sounding”, la copiatura più o meno voluta di prodotti made in Italy, come accaduto, ad esempio, con l’altrettanto celebre caso del Parmesàn, l’imitazione del Parmigiano Reggiano. In realtà, sotto, c’è molto di più. C’è soprattutto la difesa di un territorio – quello del mondo Prosecco, di cui il territorio del Conegliano Valdobbiadene rappresenta l’area “storica” – della sua storia e delle origini di un prodotto ormai famoso in tutto il mondo. Proprio per questo, e a garanzia soprattutto del consumatore finale, va difeso e tutelato.
Le tappe della “Questione Prošek”
11 dicembre 2013
Invio alla Commissione europea, da parte della Croazia, della domanda di protezione della menzione tradizionale "Prošek"
22 settembre 2021
Pubblicazione nella Gazzetta Ufficiale EU della domanda croata di riconoscimento della menzione tradizionale "Prošek"
Novembre 2021
Invio di 12 opposizioni, tra cui quella del Ministero delle politiche agricole, delle Regioni Veneto e Friuli-Venezia Giulia, dei tre Consorzi del Sistema Prosecco (Prosecco DOC, Asolo Prosecco DOCG e Conegliano Valdobbiadene Prosecco DOCG), di Federdoc e Coldiretti
Aprile 2022
Risposta croata alle opposizioni
Giugno 2022
Controdeduzioni del Ministero e delle regioni Veneto e Friuli-Venezia Giulia

autunno 2022?
Decisione finale della Commissione Europea
Una minaccia da affrontare insieme
“La tutela del nome Prosecco è un tassello fondamentale del nostro successo. Noi produttori del Conegliano Valdobbiadene riteniamo che il valore del nostro prodotto affondi le sue radici nel territorio di origine e il riconoscimento Unesco, attribuito alle colline del Prosecco di Conegliano Valdobbiadene, è il marchio della nostra unicità.
Il traguardo è stato raggiunto grazie alla sapienza dei viticoltori che per se coli hanno letteralmente ricamato queste colline, creando una perfetta ar monia tra paesaggio e lavoro dell’uomo, ovvero tra natura e cultura. Difen diamo il nome Prosecco per tutelare la tradizione che i nostri padri ci hanno trasmesso e che noi vogliamo tramandare alle generazioni future.
Nel corso dell’ultimo anno ci siamo trovati a fronteggiare una delle minacce più serie di sempre. Il Prošek croato ha bussato alla porta dell’Europa con la richiesta di riconoscimento della menzione tradizionale Prošek.
Questo avvenimento ha visto la nostra reazione compatta come Sistema Prosecco ma soprattutto il sostegno di tutte le istituzioni che con noi hanno condotto questa battaglia in difesa di un prodotto italiano, simbolo del no stro saper fare e legato saldamente ai nostri luoghi, che quindi non può in nessun modo essere imitato, anche se solo nel nome, in nessuna altra parte del mondo.
Il lavoro corale che è stato messo in campo per difendere il nome Prosecco è espressione della volontà comune di tutelare il nome Prosecco, la nostra denominazione e in generale il sistema delle denominazioni europeo, che ha l’obiettivo di valorizzare la qualità, l’origine e i metodi di produzione dei prodotti agroalimentari. Il movimento di opinione che si è animato sul caso Prošek ha larghi confini internazionali che danno la misura dell’importanza della nostra battaglia.
11 10 Conegliano Valdobbiadene Conegliano Valdobbiadene luglio /2022 luglio /2022
TUTELA TUTELA
Elvira Bortolomiol Presidente Consorzio di Tutela del Conegliano Valdobbiadene Prosecco DOCG
Presidente

Il Prosecco è un simbolo del nostro paese
“Se la nostra campagna veneta non è più conosciuta nel mondo per la povertà diffusa è anche merito del Prosecco. Un vino che ha rappre sentato un punto di svolta per moltissimi agricoltori della nostra ter ra. La produzione, infatti, si è affermata sul mercato planetario come vera eccellenza enologica. Grazie al duro lavoro, che per certe posizioni dei terre ni possiamo definire eroico, ci sono famiglie che hanno conosciuto la soddi sfazione di vivere molto più dignitosamente, di fare studiare i figli, di puntare ad una viticoltura sempre più di qualità in aziende moderne e competitive.

Per quanto riguarda il territorio le Colline del Prosecco di Conegliano e Val dobbiadene, territorio simbolo dell’eccellenza di questa produzione, sono state inserite nella lista dei siti patrimonio dell’Umanità dall’UNESCO. Stia mo parlando dell’organizzazione delle Nazioni Unite, quindi del massimo livello, che ha tra compiti anche la tutela dell’ambiente e la promozione dello sviluppo sostenibile. Il nome “Prosecco” rappresenta, quindi, una gran de realtà produttiva in cui territorio, prodotti, paesaggio e senso di identità sono unici grazie ad una cultura del lavoro millenaria. Anche durante la crisi pandemica, nostri viticoltori hanno sempre continuato a lavorare pancia a terra e un’indagine segnala che, solo negli Stati Uniti, nel 2021 il mercato del Prosecco è salito del 43%.
Il Prosecco, quindi, è un simbolo del nostro paese, una componente irrinunciabile perché identifica una produzione del Veneto e del Nordest in tutto il mondo. Sono stato io come ministro delle Politiche agricole, forestali e alimentari nel 2009 a firmare il decreto che ha istituito la Doc e le due DOCG di Conegliano Valdobbiadene e dei Colli Asolani. Avvenne quando da non molto tempo avevamo dovuto rinunciare a chiamare “Tocai”, una nostra produzione secolare per rispettare la tutela imposta sulla denominazione ungherese. Noi abbiamo dimostrato di saperci adeguare, ora ci aspettiamo che lo facciano gli altri e che l’Europa sappia far valere l’identità dei nostri prodotti e il lavoro dei nostri agricoltori. La vicenda “Prošek”, infatti, ritengo sia un banco di prova per l’Europa e non certamente per noi. Se l’Europa do vesse cedere alle richieste croate creerebbe un precedente pericolosissimo. E non mi riferisco soltanto al vino ma a tutti i prodotti tipici.
È impensabile che l’Europa possa autorizzare e legittimare l’uso del nome “Prošek”, che storicamente identifica una nostra produzione. Non ho esitato a definire questa eventualità scandalosa. Spero proprio che l’Europa dimostri un po’ di serietà. Non esiste un Prosecco prodotto fuori dai confini delle aree di denominazione. Dalle mie parti si dice: carta canta. In questo caso la carta è una riserva del nome compresa nel decreto del 2009, rico nosciuto dall’Europa. Ad essa si aggiunge il pronunciamento dell’Unesco nel 2019 che ha dichiarato Patrimonio dell’Umanità le Colline del Prosecco di Conegliano Valdobbiadene.
Se qualcuno non si accontenta e vuole sollevare che sono atti recen ti, ci sono documenti e testimonianze ben più antiche che vanno indietro nei secoli e chiariscono come il nome del Prosecco sia legato esclusivamente all’area di produzione che si riconosce nella DOC e nelle DOCG.
13 Conegliano Valdobbiadene luglio /2022
Luca Zaia
della Regione del Veneto
TUTELA

15
Valdobbiadene luglio /2022 EVENTI A CENA COL PAESAGGIO IL CONSORZIO FIRMA TRE STRAORDINARIE SERATE NELL’AMBITO DELLA CONEGLIANO VALDOBBIADENE EXPERIENCE testo di Marina Grasso foto di Francisco Marques
Conegliano
Sapori e profumi, aromi e sentori da gustare con lo sguardo, in un emozionante percorso dal paesaggio al bicchiere passando per le comunità che hanno forgiato l’aspetto del primo e riempito di piacevolezza il secondo. Sono state tre serate di esplorazione fisica, storica e sensoriale dei paesaggi più esaltanti delle Colline Patrimonio dell’Umanità UNESCO, quelle proposte da “A Cena col Paesaggio” nell’ambito della Conegliano Valdobbiadene Experience, il Festival ideato e organizzato dall’Associazione Strada del Prosecco e Vini dei colli Conegliano Valdobbiadene in sinergia con il Consorzio di Tutela del Conegliano Valdobbiadene Prosecco DOCG.
Nel programma della
Prima serata • venerdì 17 giugno
Rive, ciglioni, suoli
La sintesi aurea in un calice di Conegliano Valdobbiadene DOCG
Cena sulla collina del Collagù – Farra di Soligo



Chef Tino Vettorello

Tre cene preparate da chef di vaglia, abbinate a degustazioni guidate da Cristian Maitan (miglior Sommelier AIS del Veneto 2018) e dal nostro direttore Diego Tomasi e ambientate in tre cornici straordinarie. A cominciare, il 17 giugno, dalla collina di Collagù, con la rara e preziosa occasione di cenare in quella che fu la sala conferenze dell’osservatorio di climatologia creato a inizio Novecento dall’avvocato Giulio Bottari de Castello nella sua tenuta, testimonianza tangibile di un’attenzione scientifica all’ambiente che qui non è solo tradizione ma storia. Grazie ai suoi eredi, la famiglia Lavezzi che ha condiviso la serata con partecipanti, si è potuto accedere ad alcuni dei luoghi più iconici del sito Patrimonio UNESCO, con vista privilegiata su ardite rive e ciglioni dove la coltivazione della Glera si fa oltremodo eroica e sapori del Conegliano Valdobbiadene diventano unici, come hanno ben illustrato Maitan e Tomasi durante la degustazione di diverse tipologie di “Rive” abbinate alla cena preparata da Tino Vettorello.


17 16 Conegliano Valdobbiadene Conegliano Valdobbiadene luglio /2022 luglio /2022
17 26 giugno 2022
EVENTI EVENTI
Seconda serata • lunedì 20 giugno
Il Superiore di Cartizze
Il pentagono d’oro, una storia unica e rara per un vino inimitabile Cena sulla collina del Cartizze – Valdobbiadene
Chef Chiara Barisan, Ristorante Salis


Il secondo appuntamento, il 20 giugno, si è tenuto al Ristorante Salis, sulla collina del Cartizze, con vista sull’ingegnosità, oltre che sulla bellezza, di un anfiteatro naturale già di per sé fortunato per composizione del terreno e insolazione, ma che il lavoro dell’uomo ha saputo esaltare per creare quello che non è solo il “top di gamma” della Denominazione ma anche un vero e proprio sorso di storia sociale che quel paesaggio ha custodito e valorizzato. Suggestiva, al termine della cena realizzata da Chiara Barisan, la breve passeg giata tra i vigneti per raggiungere il servizio del dessert, gustato tra morbidi saliscendi oramai nella penombra, tra silenzi e orizzonti ricamati di vigneti dai colori cangianti al chiarore della luna.
Terza serata • giovedì 23 giugno
Radici nel futuro

Antiche e nuove varietà nel vino contemporaneo Cena nel Castello di San Salvatore – Susegana Burly’s & Nicola Tonon

Per parlare di territorio ma anche di futuro, Strada e Consorzio hanno scelto come terza location di “A Cena col Paesaggio”, il 23 giugno, lo storico Castello di San Salvatore di Susegana, emblema di un paesaggio da sempre produttivo, ancorato alle proprie tradizioni ma anche aperto alle innovazioni colturali, dove le degustazioni abbinate alla cena realizzata da Alberto Furlan e Andrea Bordignon hanno avuto come protagonisti vitigni autoctoni storici ma anche quelli del futuro. Glera, Perera, Bianchetta e Verdiso, quindi, ma anche la prima degustazione pubblica di un vino da l’inedita Glera “resistente”, varietà dalle caratteristiche innovative che potrebbe diventare la protagonista dell’enologia di domani. Perché cenare in autentiche e sontuose cartoline, per molti partecipanti (e numerosi sono stati coloro che non sono riusciti ad intervenire per esaurimento dei posti disponibili) è stato non solo un inno alla bellezza, ma anche all’intraprendenza e alla passione di chi in quel paesaggio ha coltivato viti ma anche autentica cultura enoica. E anche una sottoscri zione di volontà comune di Strada e Consorzio per continuare a promuovere insieme le mille “experiences” possibili intorno ad un calice di Conegliano Valdobbiadene Prosecco Superiore DOCG.

19 18 Conegliano Valdobbiadene Conegliano Valdobbiadene luglio /2022 luglio /2022

Conegliano Valdobbiadene 21 luglio /2022 lNCONTRI AUMENTI DEI COSTI E SCENARI FUTURI UN INCONTRO PER FARE IL PUNTO DELLA SITUAZIONE ODIERNA, PROVANDO A TRACCIARE LE LINEE FUTURE STRATEGICHE PER USCIRE DALLA CRISI incontro organizzato in collaborazione con CIRVE
Lo scorso 8 giugno il Consorzio di Tutela Conegliano Valdobbiadene Prosecco DOCG, assieme al CIRVE (UniPd), ha organizzato un incontro rivolto agli imbottigliatori del vino Prosecco SuperioreDOCG
dal titolo “Stato attuale e scenari futuri sui costi e approvvigionamenti per le imprese del vino”. La necessità di affrontare la problematica è nata dal consistente rincaro dei materiali necessari al confezionamento del vino e alle sempre maggiori difficoltà nel loro reperimento.
Il professor Eugenio Pomarici ha presentato la situazione attuale del mercato del vino che sulla base dei dati del primo trimestre del 2022 appare estremamente positi va in termini di vendite, in continuità con il 2021, ma ha anche segnalato che l’aumento dei costi sta riducendo i margini e che la crescita dell’inflazione rischia di compromettere la domanda. Di fatto, se la guerra in Ucraina dovesse prolungarsi oltre l’autunno e magari sino alla fine del 2022, la domanda di vino si potrebbe contrarre rispetto al 2021. Pomarici ha inoltre presentato le opportunità che la nuova Politica Agricola Comuni taria (PAC) e il PNRR offrono per l’autonomia energetica e quindi il controllo dei costi energetici. In questo senso, le imprese vi tivinicole potranno ricorrere all’intervento settoriale PAC e alle misure dello sviluppo rurale per ridurre consumi energetici e per autogenerare energia ed ai programmi previsti dal PNRR per l’istallazione di pannelli fotovoltaici e per l’efficientamen to energetico nel quadro dei programmi Parco Agrisolare e Agro-Voltaico.
Giuseppe Schirone di Prometeia ha spiegato poi quanto siano complicati mercati delle materie prime (vetro, plastica, carta, alluminio, chimica enologica, etc.) e quanto ciò sia aggra vato dal conflitto russo/ucraino, dalla nostra dipendenza ener getica e dalla pandemia. Rincari (mediamente +40%) che sono legati all’aumento del costo del gas, all’aumento del costo dei trasporti, del costo del legname (grande richiesta dell’edilizia) ed all’aumento del costo della carta. In una situazione come quella attuale non è facile tracciare delle previsioni, ma solo ipotizzare degli scenari che non vedranno un rientro dei costi al meno per prossimi due anni.
Per quello che riguarda il vetro, Marco Ravasi di Asso vetro ha confermato un aumento del 50%, pur rimanendo quel lo italiano il costo inferiore a livello europeo grazie alla forte concorrenza esistente tra produttori. L’industria del vetro è for temente energivora visti i costi degli altiforni. Il 70% del vetro usato per le bottiglie del vino è vetro riciclato il cui costo a livello europeo è aumentato del 22-52%. Ravasi vede come opportuno un intervento a livello governativo per mantenere prezzi alme no invariati, mentre sul fronte della domanda vedrebbe utili dei contratti comuni a lungo termine tra gli imbottigliatori a fronte di una domanda che nel 2021/22 è aumentata quasi del 10%. La frammentazione nella domanda, inoltre, non aiuta le imprese, è più opportuno fare sistema.
Secondo Filippo Pancolini di Assindustria Venetocen tro, gli italiani hanno comunque dimostrato di affrontare mol to bene le emergenze congiunturali, ma non sanno aggredire strutturalmente le problematiche guardando al futuro e agendo sull’intera filiera realizzando un “patto tra le parti”. Bisognerà coinvolgere maggiormente il sistema finanziario, migliorare i rapporti con la pubblica amministrazione, creare delle comunità energetiche, credere di più sulla formazione. Molto utile sarà la creazione di reti territoriali che sappiano dialogare.
Il presidente del Gruppo Vinicolo e Distillati Liquori As sindustria Venetocentro, Armando Serena, ha espresso grande preoccupazione perché, a fronte di un forte impegno nell’inno vazione gestionale del settore vino (come ad esempio il Codice Doganale, nato da un impegno di Federvini), di un aumento della domanda sia nei mercati interni che esteri, l’incertezza genera le crei stati di tensione, per superare i quali servono soluzioni a breve termine.
Concludendo, complessivamente, a livello globale, vi è stato un aumento nella richiesta di materie prime che ha cre ato tensione nei mercati. Ma non si prevedono comunque nuovi o consistenti aumenti dei prezzi, mentre permarrà qualche dif ficoltà nelle forniture dove certamente una maggior concen trazione della domanda con contratti a lungo termine a prezzi stabiliti potrà regolarizzare le consegne.
CONTROLLA L’OSSIGENO E IL TEMPO

Con ogni soluzione Mytik Diam, scegli il livello ideale di desorbimento dell’ossigeno dal tappo e il tempo ottimale di affinamento in bottiglia in base al profilo e alla storia del tuo vino. La gamma di tappi in sughero Mytik Diam è unica e fa della tappatura l’ultimo atto enologico. Ti permette di rispondere con precisione alle aspettative sempre più esigenti dei tuoi clienti.
Mytik Diam, il potere di scegliere www.diam-cork.com
tel. 0141/769153 · fax 0141/727496 · info@paoloaraldo.it
22 Conegliano Valdobbiadene luglio /2022
lNCONTRI
DEGUSTAZIONI IN REDAZIONE
Tre giornate milanesi dedicate ad incontri con la stampa, che hanno convolto testate e magazine degli editori Condé Nast, RCS Cairo e Stile Italia Edizioni
Durante la seconda metà del mese di maggio si sono svolti a Milano tre incontri con gli editori che hanno visto impegnato il Consorzio di Tutela sul fronte media per raccontare, attraverso una serie di attività di degustazione, tutte le carat teristiche e peculiarità delle diverse tipologie del Conegliano Valdobbiadene Prosecco DOCG.
Si è cominciato il 19 maggio scorso, con il Consorzio ospi te dell’editore Condé Nast dove ha tenuto una degustazione per presentare la Denominazione ad alcuni giornalisti di importanti magazine di settore nazionali: Anna Mazzotti di Vanity Fair, Pa ola Montanaro di GQ Angela Odone di Cucina Italiana e Pierluigi Pastres di Wired. Il 20 maggio, poi, è stata organizzata una de gustazione per alcune redazioni dell’editore RCS Cairo presso il ristorante Bioesserì in cui sono intervenute Simonetta Lipira di Io Donna ed Elisabetta Ranieri di F
Infine, il 27 maggio, presso il locale Il Santa Bistrot, sono state accolte le giornaliste che compongono le redazioni “food” dell’editore Stile Italia Edizioni, ovvero Sale & Pepe Cucina Moderna e Giallo Zafferano. Il tema è virato sull’abbinamento. Infatti, le stesse giornaliste avevano già partecipato ad una de gustazione introduttiva sulla denominazione tenuta nel 2020. In quest’occasione particolare sono intervenute Laura Maragliano, direttrice di tutte le testate, Liva Fagetti, Enza d’Alessandra, Marina Cella, Monica Pilotto, Barbara Galli, Daniela Falsitta e Silvia Bombelli
Tutti e tre gli incontri sono stati molto apprezzati, come dimostrano alcune mail di ringraziamento e complimenti, ma so prattutto di richiesta contenuti, che sono seguite subito dopo gli appuntamenti. Tutti gli ospiti sono stati naturalmente invitati sul territorio, in particolare agli appuntamenti previsti per la Cone gliano Valdobbiadene Experience di giugno.
Giornalisti a Cena col Paesaggio
In occasione della terza serata della serie “A Cena col Paesaggio”, organizzata nell’ambito della Conegliano Valdobbiadene Experience (di cui parliamo in modo appro fondito in altra parte del nostro giornale), il Consorzio ha ospitato sul territorio tre giornalisti della stampa nazio nale: Riccardo Lagorio per DOVE, Paola Pardieri per The Travel News (testata di viaggi diretta da Sara Magro, re sponsabile anche del periodico Traveler di Condè Nast) e Michela Bortoletto di Caravan e Camper.

I partecipanti sono stati molto soddisfatti dell’esperienza vissuta nelle colline di Conegliano Valdobbiadene, soprat tutto perché hanno incontrato una realtà molto autentica che in effetti non conoscevano da vicino. Dato il profilo tu ristico delle testate che gli ospiti rappresentavano, oltre alla cena con degustazione tematica al Castello di San Salvatore, il tour prevedeva una visita culturale, lungo le vie del Cima da Conegliano, trekking nella core zone del Pa trimonio Unesco accompagnati da una guida naturalistica con sosta in una tipica “casera” e visita presso un’azienda della Denominazione aderente al progetto Eno-Bee.

25 Conegliano Valdobbiadene Conegliano Valdobbiadene luglio /2022
lNCONTRI
IL CONSORZIO INCONTRA LO CHAMPAGNE
Un connubio perfetto tra due vini icona dell’enologia mondiale. Con più di un parallelismo. E in autunno, in programma nuovi incontri
Bolle, terroir e stile, questo è stato il filo conduttore che ha caratterizzato due incontri organizzati il 10 e 11 giugno scorso da Vinidea per conto del Con sorzio Conegliano Valdobbiadene Prosecco DOCG e condotti dall’esperta Daniela Guiducci, enolo ga e formatrice specializzata sui vini spumanti e la Champagne in particolare, con un contributo di Giuliano Boni, responsabile formazione Vinidea, mettendo a confronto la realtà transalpina dello Champagne e le differenti espressioni del Conegliano Val dobbiadene Prosecco Superiore DOCG.

Tanto grande è stato l’interesse, la partecipazione atten ta e gli spunti di riflessione emersi da aver spinto il Consorzio a riprogrammare altri appuntamenti aperti nel prossimo autunno, in particolare nei mesi di settembre e ottobre. Sempre dedicati ad un pubblico dei wine lovers e dei tanti curiosi e appassionati che desiderano conoscere e approfondire due vini icona del set tore vinicolo, come il Prosecco Superiore DOCG e lo Champagne appunto.
Due denominazioni apparentemente così lontane, ma ricche di possibili parallelismi come l’espressione dei diversi ter roir e luoghi d’origine in cui vengono messi in risalto la comples sa geologia dei suoli d’oltralpe, il clima, vitigni a bacca bianca e il concetto di macro, meso e micro terroir in Champagne, così come per quanto riguarda la categoria Rive per il Conegliano Valdobbiadene Prosecco Superiore DOCG. Oppure inseguendo l’impronta di stile e di longevità del vino riscontrata tra Blanc de Blancs di due regioni diverse con un parallelismo che porta drit to verso l’effetto di un diverso dosaggio zuccherino (extra brut, brut e extra dry), della rifermentazione in bottiglia (col fondo), della sosta prolungata in autoclave e del “cru” per eccellenza, il Cartizze, per l’universo del Conegliano Valdobbiadene Prosecco Superiore DOCG. I nuovi appuntamenti saranno disponibili a bre ve, completi di tutti i dettagli, sul sito www.prosecco.it.
fonte: www.enodays.com

27 26 Conegliano Valdobbiadene Conegliano Valdobbiadene luglio /2022 luglio /2022 SEMINARI
GIOVANI CICLISTI SULLE COLLINE
Il territorio ha ospitato quest’anno il Meeting Nazionale Giovanissimi: 1550 ragazzi di 168 società ciclistiche da tutt'Italia


Un tripudio di colori, di persone e di biciclette. Si può riassumere così il 34° Meeting Nazionale Giovanissimi che, dal 23 al 26 giugno, ha radu nato tra Conegliano e Farra di Soligo società e ragazzi provenienti da tutta Italia in una gran de festa per il ciclismo giovanile. Anzi, la più grande, visto che a livello nazionale non esistono manifestazioni così poderose in termini di organizzazione e numeri.

Ad orchestrare il tutto ci ha pensato la Ciclistica Provin ciale di Treviso, associazione nella quale confluiscono tutte le realtà giovanili del territorio, che aveva preso in mano le redini dell’organizzazione già nel 2018, posticipata però fino ad oggi a causa della situazione pandemica. I numeri certificano chia ramente la portata dell’evento: 1550 ragazzi partecipanti, ap partenenti a 168 società provenienti da 18 Regioni italiane (uni che assenti Calabria, Molise e Valle d’Aosta), con 300 fantastici volontari che si sono spesi per tenere tutto sotto controllo nei quattro giorni di evento.
Con più di 4 mila persone arrivate sulle Colline di Cone gliano Valdobbiadene, tra famiglie e accompagnatori, l’indotto complessivo stimato è di circa 1,5 milioni di euro. “Come pro duttori di Conegliano Valdobbiadene Prosecco Superiore DOCG siamo stati lieti di ospitare tra nostri vigneti questi giovanissimi atleti – ha detto Elvira Bortolomiol, presidente del Consorzio di Tutela del Conegliano Valdobbiadene Prosecco DOCG – perché anche questa è stata un’occasione per far conoscere la bellezza del nostro territorio a un pubblico di famiglie che hanno potuto apprezzare la cura che dedichiamo al nostro territorio. Ci augu riamo che aver pedalato tra le nostre colline abbia trasmesso l’importanza della tutela dei territori e della necessità di un agi re sostenibile da parte di tutti per garantire un futuro di salubrità e bellezza del Conegliano Valdobbiadene come di altri territori”.
29 Conegliano Valdobbiadene luglio /2022 SPORT

31 Conegliano Valdobbiadene luglio /2022 PROMOZIONE INTERNAZIONALE INCONTRI INTERNAZIONALI TANTE ATTIVITÀ PER GLI OSPITI PROVENIENTI DA REGNO UNITO, USA, NORVEGIA E AUSTRALIA, CHE SONO STATI IN VISITA AL TERRITORIO
Dopo due anni di stop a causa della pandemia, la Denominazione è tornata ad accogliere ospiti internazionali, nell’ambito dell’attività di incoming. Nel corso degli ultimi mesi, da aprile a luglio, oltre 30 tra giornalisti, sommelier, buyer, provenienti da diversi paesi quali Stati Uniti, Regno Unito, Norvegia, Australia, sono venuti in visita alle colline di Conegliano e Valdobbiadene, per scoprire e vedere da vicino, per la prima volta, quello che è diventato oggi un territorio Patrimonio UNESCO.
Per questo importante ritorno di ospiti internazionali sul territo rio, è stato predisposto un programma di attività mirato a far co noscere la realtà del Conegliano Valdobbiadene a 360° ed emo zionare visitatori. I programmi degli incoming hanno previsto attività organizzate per approfondire quegli aspetti che ne fanno un prodotto culturale, frutto di un territorio in cui la cultura del vino si unisce alla bellezza del paesaggio e all’arte.
Nell’occasione sono state organizzate visite guidate nel centro di Conegliano, sulle tracce del Cima, cene e degustazioni in ca sere situate nei più bei belvedere della Denominazione, tour in elicottero per poter ammirare le colline dall’alto e cogliere nel migliore dei modi gli elementi di unicità del territorio Patrimonio dell’Umanità ed anche tour in bici elettrica per confrontarsi di rettamente con le pendenze e la bellezza del paesaggio.


Ma si sono tenuti anche momenti di partecipazione esperienzia le più diretta e approfondita, come corsi di cucina per mettere direttamente alla prova gli ospiti nello sperimentare gli abbi namenti tra il nostro vino e la gastronomia locale ed approfon dimenti tecnici sulle peculiarità della Denominazione, i suoli ed i progetti legati alla sostenibilità, illustrati agli ospiti dal Diret tore del Consorzio, Diego Tomasi. Numerose sono state le occa sioni di incontro con produttori, attraverso le visite in cantina, degustazioni e momenti conviviali, in cui sono state coinvolte oltre 40 aziende. Ecco nel dettaglio i protagonisti degli incoming.
Dagli USA…
Dal 2 al 6 maggio, realizzata dal Consorzio in partnership con Charles Communications, si è tenuta l’attività di incoming che ha coinvolto ospiti provenienti dagli USA. In particolare, hanno partecipato Jienna Basaldu, Wine Director del Restaurant Com mis di Oakland, Moemu Seo, Assistant Wine Director dell’A16 di San Francisco/Oakland, Nicole Loewenstein, sommelier del Major Food Group di New York, Alder Yarrow, giornalista di Vino graphy e corrispondente del sito JancisRobinson.com che ha poi realizzati diversi articoli sulla sua esperienza, e Kimberly Charles dell’agenzia Charles Communications.

… e dal Regno Unito
Realizzato in partnership con IWSC (International Wine & Spirit Competition), l’incoming si è tenuto dal 23 al 26 maggio ed ha coinvolto cinque giudici del concorso. Se il focus principale della loro visita era la degustazione dei campioni iscritti al con corso, non sono mancati tour del territorio, in elicottero e a piedi, degustazioni ad alta quota sulle Rive più scoscese della Denomi nazione e incontri conviviali con i produttori. Un approfondimen to su questa iniziativa è riportato nella pagina seguente.
Incoming Norvegia e Australia
Nel mese di giugno sono stati organizzati due incoming in collaborazione con la nostra consulente Michele Shah. Per la prima volta, a inizio giugno, sono venuti in visita alla Deno minazione un gruppo di sommelier (tra cui Francesco Marzola, il Miglior Sommelier Norvegia 2020) e giornalisti norvegesi, se lezionati con la collaborazione di Liora Levi, che cura le attività del Consorzio in Norvegia. A fine giugno, invece, è stata la volta di un gruppo di giornalisti e buyer australiani, accompagnati da Tyson Stelzer, autore pluripremiato e grande esperto di vini, che stanno diventando dei veri e propri ambasciatori della nostra Denominazione, grazie ai numerosi articoli pubblicati.

33 Conegliano Valdobbiadene Conegliano Valdobbiadene luglio /2022 luglio /2022 PROMOZIONE INTERNAZIONALE
PROMOZIONE INTERNAZIONALE
BATTISTELL
IWSC: “abbuffata” di premi per la DOCG
En plein di riconoscimenti per il Conegliano Valdobbiadene Prosecco Superiore DOCG da parte di IWSC. Si tratta di 9 medaglie d’oro, 95 medaglie d’argento e 42 di bronzo as segnate a vini della nostra Denominazione Conegliano Val dobbiadene Prosecco DOCG da esperti giudici dell’IWSC del calibro di Sarah Abbott, Master of Wine dal 2008, David Kermode giornalista ed editore per emittenti e gruppi internazionali dalla ventennale esperienza nel settore Wines & Spirits, Matteo Montone Master Sommelier, Sal vatore Castano Miglior Sommelier d’Europa 2021 e infine Andrew Johnson degustatore e amministratore delegato presso Woodwinters.


“
Sono stati giorni intensi di valutazioni presso la sede del nostro Consorzio di Tutela del Vino Cone gliano Valdobbiadene Prosecco DOCG e siamo lieti di aver potuto ospitare i giudici dell’IWSC, in presenza, final mente. È stata un’occasione importante e non abbiamo esi tato a mostrare ai giudici le unicità del nostro territorio ac compagnandoli nei più bei belvedere della Denominazione.
Elvira Bortolomiol
Presidente del Consorzio di Tutela
Gli ultimi giorni di degustazione ci hanno dato una visione ancora più completa: il livello qualitativo dei partecipanti è stato incredibilmente alto. Solo una manciata di vini non ha raggiunto la medaglia. Un ri sultato del genere in un giudizio professionale sul vino è estremamente raro.

Andrew Johnson
Amministratore delegato di Woodwinters
Giudice dell'IWSC

Per chi conosceva bene la regione come me, il punto forte è stata la coerenza e la profondità delle di verse sfaccettature. La qualità dei vini presentati dimostra che produttori fanno davvero un ottimo lavoro. Abbiamo riscontrato un’incredibile coerenza su tutta la li nea, che spiega l’altissimo numero di medaglie assegnate.
David Kermode
Giornalista e giudice dell'IWSC
35 Conegliano Valdobbiadene luglio /2022
abito perfetto, cucito su
A SINCE 1961 capsulebattistella.it L
misura
PROMOZIONE INTERNAZIONALE
“
“
completo dei vincitori è disponibile sul sito di IWSC https://iwsc.net
L’elenco
Social in USA
Continua la promozione del Conegliano Valdobbiadene Prosecco Superiore nei paesi chiave USA e Inghilterra, in ottica sempre più digital. Numerosi sono i progetti in programma a partire dalla seconda metà del 2022 per quanto riguarda la comunicazione digitale internazionale nei paesi chiave dove il Consorzio di Tutela ha deciso di investire.

Sono stati fatti investimenti tramite principali portali specializzati, dove verranno pubblicati numerosi banner e pubbliredazionali, e selezionati siti di news ed e-commerce, come l’importante catena americana di vini e distillati Binny’s. È di rilievo segnalare anche la collaborazione con il portale americano Wine Folly, in cui a novembre pubblicheremo la Guida Digitale sulla nostra Denominazione. Si tratta di un portale seguito da 20 milioni di persone all’anno, principalmente negli Stati Uniti, Canada e Regno Unito, che includerà la nostra Region Guide, un format innovativo e dinamico che permetterà ai wine lovers di scoprire la Denominazione nelle sue diverse sfaccettature, dalla spiegazione dei diversi terroir al paesaggio UNESCO, dalle tipologie di Conegliano Valdobbiadene Prosecco Superiore DOCG alla storia, dall’enoturismo fino ad una sezione interamente dedicata alle singole cantine, con l’obiettivo di far emergere tutti gli elementi di valore del nostro vino.

Una curiosa novità sarà la nostra collaborazione con “I’ll drink to that” di Levi Dalton uno dei più importanti Podcast americani dedicato esclusivamente al mondo del vino, che con una campagna pubblicitaria che verrà trasmessa in diversi stati americani metterà in luce le peculiarità e il valore del nostro territorio e del nostro Spumante.


Novità su Instagram: @proseccocv
Anche Instagram continua ad essere un importante veicolo per la nostra comunicazione digitale, come ad esempio il progetto Plates & Playlists che vedrà come protagonisti quattro star ed influencers americani che tramite il formato Reels racconteranno gli stili del nostro Conegliano Valdobbiadene Prosecco Superiore DOCG abbinandolo non solo a dei piatti preparati ad hoc ma anche ad un preciso stile musicale.
Continuano anche gli incoming esperienziali dall’estero sul nostro territorio con l’obiettivo di rendere gli interessati protagonisti di esperienze uniche ed emozionanti che permettano loro di scoprire la ricchezza paesaggistica e culturale delle nostre colline. A settembre sarà il turno di un gruppo di influencers inglesi, tra cui avremo il piacere di ospitare anche la Master of Wine canadese Christine Marsiglio. Il programma è fitto di attività e non vediamo l’ora di accoglierli. Il reportage del loro incoming come sempre verrà pubblicato nella nostra pagina Instagram @proseccocv.
37 36 Conegliano Valdobbiadene Conegliano Valdobbiadene luglio /2022 luglio /2022 DIGITAL DIGITAL
…dicono di noi

È stato un trimestre ricchissimo di uscite per la nostra Denominazione, sulla stampa cartacea come in tv e sui siti online. Merito soprattutto dell’ultimo Vinitaly, che ha visto la presentazione degli ultimi dati economici, ma anche della ripresa di molte attività sul territorio: visite, eventi e incontri a tema. Ecco, come al solito, il meglio uscito negli scorsi mesi.
Ambiente e Sostenibilità
Il 10 aprile Decanter, la trasmissione di Rai Radio 2 condotta da Federico Quaranta e Tinto ha avuto come ospite la presidente del Consorzio di Tutela Elvira Bortolomiol, che sul tema della sostenibilità ambientale ha detto: «La sostenibilità è un aspetto importantissimo ed ancora di più nella denominazione del Cone gliano Valdobbiadene. Qui i produttori hanno davvero lavorato per raggiungere risultati impor tanti come la certificazione SQNPI. Abbiamo avviato poi il distretto del biologico e inoltre stiamo pubblicando il nuovo protocollo di gestione sostenibile del vigneto in cui stiamo lavorando su problematiche importanti come la flavescenza dorata».

Il Giorno, il 9 maggio, dedica due articoli di Lorenzo Frassoldati alla Denominazione. Il primo dal titolo “Il Prosecco DOCG brinda a crescita e sostenibilità”, oltre a raccontare del duplice traguar do nel 2021 dei volumi che raggiungono i 104,7 milioni di bottiglie e del valore che supera i 621 milioni di euro, affronta anche il tema della viticoltura sostenibile. Scrive l’autore: «La totalità della produzione del Prosecco DOCG vede le case spumantistiche attente ad una ge stione ambientalmente sostenibile in vigneto, che va dal Sistema nazionale di qualità di produzio ne integrata/Sistema di Regione Veneto di qualità verificata, al Protocollo Viticolo fino ai metodi biologico e biodinamico. “Oggi possiamo vantare 2884 ettari certificati SQNPI pari al 33,1% della superficie vitata – conferma Diego Tomasi direttore del Consorzio di Tutela – e il nostro obiettivo è arrivare a fine anno al 45% e alla totalità delle aziende nel 2029».
Il secondo articolo, sempre a firma Frassoldati, è invece dedicato al Protocollo Viticolo, dal titolo “Un protocollo a tutela della produzione e del paesaggio” nel quale vengono segnalati i progetti Vigneto Plastic Free e Via delle Api, due progetti avviati dal consorzio come impegno per la soste nibilità che stanno coinvolgendo sempre di più viticoltori.
Sul sito di Salepepe.it lo scorso 27 maggio è uscito un pezzo di Francesca Ciancio dal titolo “Co negliano Valdobbiadene Prosecco Docg all’insegna della sostenibilità”, in cui la presidente Elvira Bortolomiol, sottolinea il legame sempre più forte tra vino e territorio: «Entro fine anno – dice la presidente – puntiamo alla nascita ufficiale del Biodistretto del Cone gliano Valdobbiadene, primo caso in Italia di sistema produttivo biologico dedicato alle bollicine. Nel frattempo, abbiamo adottato la certificazione SQNPI (Sistema Qualità Nazionale Produzione Integrata) e oggi possiamo vantare 2884 ettari certificati pari al 33,1% della superficie vitata. Abbiamo eliminato totalmente l’uso di glifosate e ciò fa di noi la zona glifosate free più estesa d’Europa. Sono tutte voci che rientrano nel Protocollo Viticolo adottato dal 2011 e che si aggiorna anno dopo anno ascoltando la voce di tutti i soci del Consorzio che, in questo modo, hanno un vero e proprio vademecum in grado di supportarli verso pratiche sempre più compatibili con l’integrità del territorio».
Quattro giorni dopo, il 31 maggio, il magazine online dedica un altro servizio alla Denominazione titolato “Conegliano Valdobbiadene Prosecco Superiore DOCG: 4 assaggi speciali” che propone un viaggio sensoriale attraverso 4 tipologie della Docg, realizzate in sottozone diverse, dalle Rive al Cartizze, passando per la versione sui lieviti, degustate dalla redazione al Santa Bistrot di Mi lano ed abbinate alle ricette create dallo chef Stefano Grandi.


Sul sito Iodonna.it il 20 maggio nell’ambito di un articolo di Giulia Cimpanelli titolato “Giornata Mondiale delle Api 2022: le iniziative dedicate ai preziosi insetti” si parla anche della nostra De nominazione nel trafiletto “Un progetto con i più fragili, nei vigneti del Prosecco” «Tra i filari del Consorzio del Conegliano Valdobbiadene Prosecco DOCG, la biodiversità è un teso ro da preservare. Ecco perché, per celebrare il World Bee Day, sono state coinvolte realtà del ter ritoriochesostengonoledisabilitàperdecorarelearnie”.L’ideaècheilterritoriosiaunpatrimonio comune da tutelare e che la sua sostenibilità passa anche per il coinvolgimento dei più fragili. Le piccole casette customizzate sottolineano così l’importanza della sensibilizzazione in tema. E la delicatezza dell’insetto incontra valorizza anche la fragilità sociale, in un circolo virtuoso».
Territorio ed Eventi
Linea Bianca, la rubrica settimanale di Rai 1 dedicata alla montagna e condotta da Massimiliano Ossini, ha dedicato l’intera puntata del 9 aprile, di ben 44 minuti, al territorio del Conegliano Val dobbiadene e ai suoi dintorni, concentrandosi sul tema del turismo sostenibile, da Vidor a Vittorio Veneto, raccontando l'ambiziosa sfida del progetto storico naturalistico del primo Cammino del le Colline del Prosecco di Conegliano e Valdobbiadene, diventate Patrimonio UNESCO nel 2019, un percorso di 52 chilometri che attraverso tutta la Denominazione. Al suo interno interviste al giornalista e scrittore Giovanni Carraro, autore del percorso, alla presidente dell'Associazione per il Patrimonio delle Colline del Prosecco di Conegliano e Valdobbiadene Marina Montedoro, all’ex-ciclista professionista e ora produttore Marzio Bruseghin, al fabbro-artista Valentino Moro e a molti altri.




Borghi Magazine, il mensile dedicato al turismo di nicchia, nel numero di giugno pubblica un arti colo scritto da Alberto Pastorella titolato “Le colline dell’UNESCO”, dedicato alle piacevoli soste intorno a Valdobbiadene, in cui l’autore scrive:

«Le Colline del Prosecco di Conegliano e Valdobbiadene, nel nord-est dell'Italia, rappresentano un paesaggio caratterizzato da dorsali collinari, ciglioni (piccoli vigneti su strette terrazze erbo se), foreste, villaggi e coltivazioni. Per secoli questo terreno aspro è stato modellato e adattato dall'uomo e sin dal 17° secolo l'uso dei ciglioni ha creato un particolare paesaggio a scacchiera formato da filari di viti parallele e verticali rispetto alla pendenza».

Diversi media si sono occupati della presentazione dell’evento “A Cena col Paesaggio”, tre cene tematiche organizzate a fine giugno nell’ambito della Conegliano Valdobbiadene Experience. Come Lacucinaitaliana.it il 12 giugno nella rubrica “Viaggi di Gusto” in cui la presidente Bortolo miol afferma: «Siamo lieti di collaborare a questa edizione. Ancora una volta abbiamo l’opportu nità di valorizzare il territorio attraverso il prodotto, in stretta collaborazione».
Anche Oggi.it il 14 giungo parla dell’iniziativa, in un servizio complessivo dedicato alle date golose da non perdere “Birre, vini naturali, barbera, prosecco, oliveti, picnic (anche stellati) e… il tendone da circo di Fellini. Quante occasioni per assaggiare e degustare il buono”. Infine, il 22 giugno ne ha parlato anche l’inserto Cook del Corriere della Sera
Sul sito specializzato Igrandivini.com il 14 maggio Agata Cappelletto racconta “Il Valdobbiadene Prosecco DOCG a Prowein 2022”, scrivendo: «Sarà quindi il Conegliano Valdobbiadene Prosecco Superiore DOCG a parlare a questo Prowein con l’annata 2021 che porta nei calici un vino capace di esprimere a pieno il profilo della Denomi nazione. La poliedricità del suo territorio e l’ampiezza dei sentori parlano delle diverse zone del territorio, delle diverse esposizioni e dei diversi metodi di gestioni del vigneto».
39 38 Conegliano Valdobbiadene Conegliano Valdobbiadene luglio /2022 luglio /2022
…dicono di noi
…dicono di noi …dicono di noi

Dati economici
Con la presentazione del Rapporto Flash durante l’ultimo Vinitaly, tanti sono stati i media e la stampa ad evidenziare la grande crescita del valore della Denominazione. Partiamo dall’inserto L’Economia del Corriere della Sera con un servizio uscito il 11 aprile intitolato “Crescono estero e digitale: Prosecco, la marcia continua”. Nel quale la presidente Bortolomiol spiega: «I dati indicano che il valore del prodotto è aumentato e questi risultati sono il frutto dell'impe gno con cui la Denominazione ha affrontato un anno difficile come il 2020 per mantenere e rin novare le relazioni con il mercato, attraverso la ricerca di nuovi canali di vendita e un'innovativa strategia di comunicazione e promozione».




All’interno della rubrica di approfondimento settimanale di Rai 2 Re Start lo scorso 11 aprile si è parlato di evoluzione del conflitto russo/ucraino ed effetto delle sanzioni, anche con riferimento al mondo del vino, con un’intervista della presidente Bortolomiol, realizzata durante la 54° edi zione del Vinitaly, sul problema dei rincari. «I produttori – ha spiegato – hanno comunque formu lato nuovi listini che hanno già compreso in parte questi nuovi rincari nei primi mesi dell’anno, sui quali abbiamo avuto dei riscontri molto positivi».
Anche il TG 3 Regione Veneto nel suo servizio dell’11 aprile titolato “Prosecco Docg, crescita in volumi e valore”, ha fatto il punto dei dati presentati, evidenziando, oltre alle 104,7 mil bottiglie vendute, l’evoluzione dei mercati esteri, con Gran Bretagna primo mercato, con un più 18,2% nelle vendite, seguita da Germania e Svizzera, e la netta ripresa anche del mercato statunitense. Nel servizio la presidente Elvira Bortolomiol ha detto: «Quel che è più positivo è l'aumento del valore della nostra bottiglia e questo ci fa pensare che tutto quello che oggi abbiamo potuto fare all’interno del Consorzio, anche con i nostri produttori, e soprattutto il fatto di essere un patrimonio UNESCO, ci permette di avere un valore più impor tante e di essere riconosciuti sui mercati».
Ancora dal Vinitaly, il giornalista Luciano Ferraro ha intervistato dal salotto di Cook-Corriere del la Sera la presidente Bortolomiol, in un servizio uscito poi su CorriereTv il 13 aprile dal titolo “Prosecco DOCG, aumenta il valore delle bottiglie”: «La nostra Denominazione – ha detto la presidente – è caratterizzata anche da Cru, che noi chia miamo Rive. Sono le colline più scoscese, le parti che abbiamo evidenziato con maggiori caratte ristiche di terroir, che possono poi essere identificate sulla bottiglia, e sulle quali noi cerchiamo di costruire il nostro futuro».

Sul canale digital video di Milano Finanza, è invece uscito il 15 aprile un servizio nell’ambito della trasmissione Food economy condotta da Tarsia Trevisan, sempre dedicato al Vinitaly 2022, che nell’ambito della crescita a doppia cifra delle bollicine italiane, che parte dal fenomeno Prosecco, ha evidenziato i dati del Rapporto Flash 2001, con un intervista alla presidente Bortolomiol, che ha detto:
«Oggi siamo una Denominazione in crescita, ma cosa più importante è che è cresciuto il valore delle nostre bottiglie. Sicuramente dovuto al riconoscimento da parte del mercato del valore non solo di una viticoltura eroica ma anche del territorio a Patrimonio dell’Umanità UNESCO».
In lungo articolo di 6 pagine pubblicato il 28 aprile su Tre Bicchieri a cura di Loredana Sottile, titolato “Prosecco DOCG: il futuro si costruisce sul valore”, fa un’ampia e completa fotografia della Denominazione, anche attraverso un’intervista della presidente Bortolomiol. La giornalista scrive:

«Era il 29 gennaio del 1995 quando Stefano Bonilli, fondatore del Gambero Rosso, pubblicava un articolo sul Corriere della Sera dal titolo “Spumante, questo sconosciuto”, elogiando i Prosecchi delle colline di Conegliano, allora tutt’altro che di tendenza. Oggi, a quasi trent'anni di distanza,
il nome Prosecco DOCG è noto in tutto il mondo e la sua produzione ha toccato quella che pro babilmente sarà il limite fisico massimo: 104,7 milioni di bottiglie, totalizzando 621,4 milioni di euro. Ma il dato degno di nota del 2021 – quello che possiamo definire l'anno della svolta – è che la crescita a valore ha superato quella a volume: +18% contro +14% così come emerge dall'ante prima del Rapporto economico della DOCG realizzato dal professor Eugenio Pomarici del CIRVE».
Internazionale

Alder Yarrow è stato definito dal San Francisco Magazine "la più brillante cyberstar del mondo del vino" ed è ampiamente riconosciuto come un pioniere del wine blogging. Nel gennaio 2004 ha fondato Vinography, che è diventato rapidamente uno dei blog sul vino più influenti del web. A seguito della sua visita alla Denominazione di inizio maggio, Alder ha dedicato due articoli al Conegliano Valdobbiadene Prosecco Superiore DOCG. Il primo, "You Think You Know Prosecco?
Wait Until You Meet Sui Lieviti" (Pensi di conoscere il Prosecco? Aspetta di incontrare il Sui Lieviti) è dedicato alla tipologia che più l’ha appassionato durante le giornate e le degustazioni nel ter ritorio. Il secondo, "Prosecco At its Finest: Highlights From My Recent Trip" (Il Prosecco nella sua migliore espressione: i punti salienti del mio recente viaggio) contiene invece diverse riflessioni sulla Denominazione nel suo complesso, per concludere con un plauso al nostro vino che «offre aromi floreali e di mela meravigliosamente freschi, croccanti e precisi che, possono essere mera vigliosamente rinfrescanti e deliziosi».
Des Houghton, giornalista australiano, ha recentemente visitato la Denominazione, durante un incoming organizzato dal Consorzio a fine giugno. A seguito del suo viaggio, ha pubblicato l’artico lo “In praise of posh new-age Prosecco” (In lode del raffinato Prosecco di nuova generazione) sul Sunday Mail, testata di riferimento della città di Adelaide, nel South Australia, con 350.000 copie stampate e oltre 700.000 abbonati on line.
Ha inoltre scritto un secondo articolo su Skynews dal titolo “Gli italiani puntano all'Australia con un Prosecco di alta gamma proveniente dalla provincia di Treviso” in cui descrive le peculiarità del territorio delle colline del Conegliano Valdobbiadene e gli elementi alla base della sua qualità.
Sara Døscher è una giornalista norvegese specializzata nell’ambito del vino ed autrice di diversi libri, che ha visitato la Denominazione a giugno, insieme ad un gruppo di sommelier, operatori della ristorazione e della stampa. A seguito della sua visita alla Denominazione ha pubblicato un articolo sulla versione cartacea e on line di Verdens Gang, quotidiano stampato in circa 100.000 copie, con una media di 2 milioni di lettori al giorno on line. L’articolo si intitola “Prosecco!... Er ikke bare Prosecco” (Il Prosecco! Non è solo Prosecco) e descrive quanto sia cambiata la sua percezio ne della qualità di questo vino, dopo averne conosciuto direttamente il territorio di produzione e le diverse espressioni del Prosecco Superiore, tra cui le Rive e il Cartizze.

41 40 Conegliano Valdobbiadene Conegliano Valdobbiadene luglio /2022 luglio /2022
LA STRADA STORICA DEL CONEGLIANO VALDOBBIADENE
/The historical route of Conegliano Valdobbiadene
STRADA PANORAMICA /Panoramic Road
Zone di produzione DOCG RIVE Spumante /Production area DOCG RIVE Spumante
100 Km da Venezia /100 Km from Venice 100 Km dalle Dolomiti /100 Km from Dolomites
ASOLO
DOCG RIVE Spumante
/DOCG RIVE Spumante
COMUNE DI VALDOBBIADENE
Rive di SAN VITO
Rive di BIGOLINO
Rive di SAN GIOVANNI
Rive di SAN PIETRO DI BARBOZZA
Rive di SANTO STEFANO
Rive di GUIA
COMUNE DI VIDOR
Rive di VIDOR
Rive di COLBERTALDO
COMUNE DI MIANE
Rive di MIANE
Rive di COMBAI
Rive di CAMPEA
Rive di PREMAOR
COMUNE DI FARRA DI SOLIGO
Rive di FARRA DI SOLIGO
Rive di COL SAN MARTINO
Rive di SOLIGO
COMUNE DI FOLLINA
Rive di FOLLINA
Rive di FARRÒ
COMUNE DI CISON DI VALMARINO
Rive di CISON DI VALMARINO
Abbazia di Follina
Via Giazzera 12 31051 Follina (TV) t/ 333 80 50 852 info@abbaziafollina.com
Adami
Via Rovede 27 - Colbertaldo 31020 Vidor (TV) t/ 0423 982 110 info@adamispumanti.it
Adamo Canel
SOCI CONSORZIO CONEGLIANO VALDOBBIADENE PROSECCO DOCG
Aletheia General Fiorone 17 31044 Montebelluna (TV) t/ 335 62 900 63 az.agricola.aletheia@gmail.com
Alterive
Via Giarentine 7 - Col San Martino 31010 Farra di Soligo (TV) t/ 0438 898 187 alterivezilli@libero.it
Altinate
Via Castelletto 73 - Col San Martino 31010 Farra di Soligo (TV) t/ 0438 898 112 info@adamocanel.it
Adriano Adami
Via Rovede 27 - Colbertaldo 31020 Vidor (TV) t/ 0423 982 110 info@adamispumanti.it
Via Cal de Medo 11 31053 Pieve di Soligo (TV) t/ 348 42 27 442 altinate@live.com
Andrea Da Ponte Corso Mazzini 14 31015 Conegliano (TV) t/ 0438 933 011 daponte@daponte.it
PROSECCO
Rive di ROLLE
COMUNE DI PIEVE DI SOLIGO
Rive di PIEVE DI SOLIGO
Rive di SOLIGHETTO
COMUNE DI REFRONTOLO
Rive di REFRONTOLO
COMUNE DI SAN PIETRO DI FELETTO
Rive di SAN PIETRO DI FELETTO
Rive di RUA DI FELETTO
Rive di SANTA MARIA DI FELETTO
Rive di SAN MICHELE DI FELETTO
Rive di BAGNOLO
COMUNE DI TARZO
Rive di TARZO
Rive di RESERA
Rive di ARFANTA
Rive di CORBANESE
COMUNE DI SUSEGANA
Rive di SUSEGANA
Rive di COLFOSCO
Rive di COLLALTO
COMUNE DI VITTORIO VENETO
Rive di FORMENIGA
Rive di COZZUOLO
Rive di CARPESICA
Rive di MANZANA
COMUNE DI CONEGLIANO
Rive di SCOMIGO
Rive di COLLALBRIGO-COSTA
Rive di OGLIANO
COMUNE DI SAN VENDEMIANO
Rive di SAN VENDEMIANO
COMUNE DI COLLE UMBERTO
Rive di COLLE UMBERTO
Agostinetto Bruno Strada Piander 7 - Saccol 31049 Valdobbiadene (TV) t/ 0423 972 884 info@agostinetto.com
Agostinetto Ivan Strada di Saccol 27 31049 Valdobbiadene (TV) t/ 0423 973 745 ivan85@tiscali.it
Agostinetto Michela Via Roccat e Ferrari 13 31049 Valdobbiadene (TV) t/ 0423 950 483 miky.agos@libero.it
Agriccolò
Via Podgori 12 31020 San Pietro di Feletto (TV) t/ 345 088 10 55 niccolò@agriccolo.it
Ai Roré
Via Patrioti 2 31020 Refrontolo (TV) t/ 0438 894 241 airore-destefani@libero.it
Al Canevon
Via Pra Fontana 99 31049 Valdobbiadene (TV) t/ 0423 972 403 info@alcanevon.it
Al Col Via Col 10 31051 Follina (TV) t/ 0438 970 658 info@alcol.tv
Al Roccolo
Via Casale Contraverser - Combai 31050 Miane (TV) t/ 0438 989 448 moreno.guizzo85@gmail.com
Andreola Via Cavre 19 31010 Farra di Soligo (TV) t/ 0438 989 379 info@andreola.eu
Antiche Terre Dei Conti Via Guido Rossa 7 31058 Susegana (TV) t/ 0438 27074 info@anticheterredeiconti.it
Antoniazzi Dario
Via Foltran 12 - Corbanese 31020 Tarzo (TV) t/ 0438 564 144 antoniazzidario@libero.it
Antoniazzi Remigio Via San Michele 56 - San Michele 31020 San Pietro di Feletto (TV) t/ 0438 64 102 - 0438 62 114 remigio.antoniazzi@alice.it Astoria Viale Antonini 9 31035 Crocetta del Montello (TV) t/ 0423 6699 info@astoria.it
Bacio della Luna Via Rovede 36 - Colbertaldo 31020 Vidor (TV) t/ 0423 983 111 info@baciodellaluna.it
Baldassar Marino Via Valbona 13/A 31020 San Pietro di Feletto (TV) t/ 0438 784 190
Baldi
Via Marcorà 76 - Ogliano 31015 Conegliano (TV) t/ 333 42 66 341 info@proseccobaldi.it
Ballancin Lino
Via Drio Cisa 11 - Solighetto 31053 Pieve di Soligo (TV) t/ 0438 842 749 viniballancin@viniballancin.com
Balliana Cirillo
Via Gravette 45 31010 Farra di Soligo (TV) cirilloballiana@gmail.com
Bazzo
Via Pianale 57 - S. Maria di Feletto 31020 San Pietro di Feletto (TV) t/ 0438 784 149 bazzopaolo@alice.it
Bellenda
Via Giardino 90 - Carpesica 31029 Vittorio Veneto (TV) t/ 0438 920 025 info@bellenda.it
Bellussi Via Erizzo 215 31049 Valdobbiadene (TV) t/ 0423 983 411 info@bellussi.com
Belvedere
Via Campion 18/A 31014 Colle Umberto (TV) roberto.rizzo@solidworld.it
Bepin De Eto Via Colle 32/A 31020 San Pietro di Feletto (TV) t/ 331 59 29 517 info@bepindeeto.it
Bernardi
Via Peron 1 - Pedeguarda 31051 Follina (TV) t/ 0438 980 483 - 0438 842 468 bernarditan@libero.it
Bernardi Luigi e Emilio
Via Peron 2 - Pedeguarda 31051 Follina (TV) t/ 0438 980 483 - 0438 842 468 andreabernardi9797@gmail.com
Bernardi Pietro e Figli
Via Mercatelli 10 - Sant’Anna 31058 Susegana (TV) t/ 0438 781 022 info@bernardivini.com
Biancavigna Via Montenero 8/C 31015 Conegliano (TV) t/ 0438 788 403 info@biancavigna.it
Bisol Via Follo 33 - Santo Stefano 31049 Valdobbiadene (TV) t/ 0423 900 138 info@bisol.it
Bival Via Rive della Sente 1 31049 Valdobbiadene (TV) t/ 347 087 11 47
bivalvaldobbiadene@gmail.com
Borghi Francesco
Borgo Olarigo 43 31029 Vittorio Veneto (TV) t/ 0438 553 241 borghi.francesco@icloud.com
Borgo Antico
Strada delle Spezie 39 - Ogliano 31015 Conegliano (TV) t/ 0438 788 111 info@borgoanticovini.com
Borgo Molino
Via Negrisia 18 31024 Ormelle (TV) t/ 0422 851 625 info@borgomolino.it
Borgoluce Località Musile 2 31058 Susegana (TV) t/ 0438 435 287 info@borgoluce.it
Bortolin Angelo Via Strada di Guia 107 31049 Valdobbiadene (TV) t/ 0423 900125 info@bortolinangelo.com
Bortolin F.lli
Via Menegazzi 5 Santo Stefano 31049 Valdobbiadene (TV) t/ 0423 900135 info@bortolin.com
Bortolin Gregorio Via Santo Stefano 2 31049 Valdobbiadene (TV) t/ 0423 975296 info@casalinaprosecco.it
Bortolomiol Via Garibaldi 142 31049 Valdobbiadene (TV) t/ 0423 9749 info@bortolomiol.com
Bottega Vicolo A. Bottega 2 - Bibano 31010 Godega di S. Urbano (TV) t/ 0438 4067 info@bottegaspa.com
Brancher Via dei Prà 23/A - Col San Martino 31010 Farra di Soligo (TV) t/ 0438 898403 mail@brancher.tv
Brun Giuliano Località Resera 44 31020 Tarzo (TV) gbrunt@alice.it
45 44
PROSECCO SUPERIORE DOCG Area di produzione Production zone
VALDOBBIADENE PROSECCO SUPERIORE DOCG Area di produzione Production zone
CONEGLIANO
DOC Area di produzione Production zone
di Treviso The Province of Treviso La
Qualitativa /The Quality Pyramid
mondo del Prosecco /The world of Prosecco
Superiore di Cartizze DOCG sottozona di 108 ettari
VALDOBBIADENE Prosecco Superiore Rive DOCG 43 Rive
VALDOBBIADENE Prosecco Superiore DOCG 15 Comuni Asolo Prosecco DOCG Prosecco DOC Treviso Prosecco DOC
Provincia
Piramide
Il
VALDOBBIADENE
CONEGLIANO
CONEGLIANO
Venezia
Trieste Treviso
Conegliano
Valdobbiadene Asolo
FRIULI
VENETO
Brunoro
Str. Chiesa 8 - S. Pietro di Barbozza 31049 Valdobbiadene (TV) t/ 0423 973 553 info@varaschin.com
Brustolin Lino
Via Roma 203 31020 Vidor (TV) t/ 0423 987 038
Buffon Giorgio
Via Ferrovia 18 - C. Roganzuolo 31020 San Fior (TV) t/ 0438 400 624 info@vinibuffon.it
Buffon Paolo e Renzo
Via Belcorvo 38 31010 Godega di S. Urbano (TV) t/ 0438 782 292 buffon@tenutabelcorvo.tv
Buso Beniamino
Via Casale Vacca 3 31050 Miane (TV) t/ 0438 893 130 info@borgorive.it
Ca’ Borgh
Via Galinera 5 31020 San Pietro di Feletto (TV) t/ 0438 784 022
Ca’ Dal Molin Via Cornoler 22 31049 Valdobbiadene (TV) t/ 0423 981 017 cadalmolin1@gmail.com
Ca' dei Fiori
Via Strada di Guia 5 31049 Valdobbiadene (TV) t/ 0423 900 182 info@cadeifiorivini.it
Ca’ dei Zago
Via Roccolo 6 - S. Pietro di Barbozza 31049 Valdobbiadene (TV) t/ 0423 975 395 info@cadeizago.it
Ca’ di Rajo
Via Del Carmine 2/2 31020 San Polo di Piave (TV) t/ 0422 855 885 info@cadirajo.it
Ca’ Piadera
Via Piadera 6 31020 Tarzo (TV) t/ 348 53 02 113 info@capiadera.com
Ca’ Vittoria
Strada delle Caneve 33 31015 Conegliano (TV) t/ 0438 63 851 info@cavittoria.com
Campea
Via Rossini - Campea 31050 Miane (TV) t/ 0423 900 138 info@bisol.it
Campion
Via Campion 2 - San Giovanni 31049 Valdobbiadene (TV) t/ 0423 980 432 - 0423 982 020 info@campionspumanti.it
Canella
Via Fiume 7 30027 San Donà di Piave (TV) t/ 0421 524 46 info@canellaspa.it
Canevel
Via Roccat e Ferrari 17 31049 Valdobbiadene (TV) t/ 0423 975 940 segreteria@canevel.it
Cantina Bernardi
Via Colvendrame 25 31020 Refrontolo (TV) t/ 0438 894 153 bernardi@cantinabernardi.it
Cantina Colli del Soligo
Via L. Toffolin 6 - Solighetto 31053 Pieve di Soligo (TV) t/ 0438 840 092 info@collisoligo.com
Cantina di Conegliano e V. Veneto Via Del Campardo 3 - San Giacomo 31029 Vittorio Veneto (TV) t/ 0438 500 209 info@cantinavittorio.it
Cantina Ponte Vecchio Via Monte Grappa 53 31020 Vidor (TV) t/ 0423 981 363 floriano@pontevecchio.tv.it
Cantina Produttori di Valdobbiadene Via S. Giovanni 45 - San Giovanni 31049 Valdobbiadene (TV) t/ 0423 982 070 valdoca@valdoca.com
Cantina Progettidivini
Via I° Settembre 20 - Soligo 31010 Farra di Soligo (TV) t/ 0438 983 151 info@progettidivini.com
Cantina Sociale Montelliana e dei Colli Asolani Via Caonada 1 31044 Montebelluna (TV) info@montelliana.it
Cantine Maschio Via Cadore Mare 2 31028 Visà (TV) t/ 0438 794 115 cantinemaschio@riunite.it
Cantine Umberto Bortolotti Via Arcane 6 31049 Valdobbiadene (TV) t/ 0423 975 668 info@bortolotti.com
Cantine Vedova Via Erizzo 6 31049 Valdobbiadene (TV) t/ 0423 972 037 cantine@cantinevedova.com
Carmina Az. Loggia del Colle
Via Mangesa 10 31015 Conegliano (TV) t/ 0438 237 19 info@carmina.it
Carobolante Daniele
Via Caviglia 65/A 31015 Conegliano (TV) t/ 0438 654 059 danielecarobolante@gmail.com
Carpené Malvolti Via A. Carpené 1 31015 Conegliano (TV) t/ 0438 364611 info@carpene-malvolti.com
Casagrande Andrea Via Trieste 4 31020 S. Pietro di Feletto (TV) t/ 347 63 52 764 floricoltura.manzana@libero.it
Casa Terriera Via Immacolata Lourdes 92/A 31015 Conegliano (TV) t/ 0438 242 10 info@casaterriera.it
Casali Luigi Via Della Cava 2 - Santo Stefano 31040 Valdobbiadene (TV) t/ 0423 900 157
Casalini Andrea Via Scandolera 84 - Colbertaldo 31020 Vidor (TV) t/ 0423 987 154 info@casalinispumanti.it
Castelir Via Canal Vecchio 14 - Col S. Martino 31010 Farra di Soligo (TV) t/ 0438 898 356
Castellalta Via Castella 17/A 31020 San Pietro di Feletto (TV) t/ 347 78 06 498 info@castellalta.it
Castello Via Roma 178 31020 Vidor (TV) t/ 0423 987 379 agr.castello@libero.it
Ce.Vi.V. Via Rive 10 - Colbertaldo 31020 Vidor (TV) t/ 0423 986 020 segreteria@ceviv.com
Cenetae
Via J. Stella 34 31029 Vittorio Veneto (TV) t/ 0438 552 043 segreteria@idsc-vv.it
Ceotto Vini
Via San Luca 11 31058 Susegana (TV) t/ 0438 780 112 info@ceottovini.it
Cepol Via Roccat Ferrari 28 31049 Valdobbiadene (TV) t/ 0423 973 746 Info@Cepol.eu
Ceschin Giulio Via Colle 13 31020 San Pietro di Feletto (TV) t/ 0438 486676 mceschin1884@yahoo.com
Ciodet Via Piva 104 31049 Valdobbiadene (TV) t/ 0423 973131 prosecco@ciodet.it
Colle Regina Via Lierza 23 31058 Susegana (TV) t/ 340 24 17 525 marianna.colleregina@gmail.com Col Del Balt Via San Giacomo 3 31049 Valdobbiadene (TV) t/ 340 16 55 860 info@coldelbalt.com
Col del Lupo Via Rovede 37 31020 Vidor (TV) t/ 0423 980 249 info@coldellupo.it
Col di Brando Via Guizza Bassa 24 30037 Scorzè (VE) t/ 328 7696620 info@terraevigne.com
Col Miotin Via Peron 7 31053 Pieve di Soligo (TV) t/ 0438 842 469 info@colmiotin.it
Col Vetoraz Str. delle Treziese 1 - S. Stefano 31049 Valdobbiadene (TV) t/ 0423 975 291 info@colvetoraz.it
Colesel
Via Vettorazzi e Bisol 4 31049 Valdobbiadene (TV) t/ 0423 901 055 info@colesel.it
Colsaliz
Via Colvendrame 48/B 31020 Refrontolo (TV) t/ 0438 894 026 info@colsaliz.it
Colvendrà
Via Liberazione 39 31020 Refrontolo (TV) t/ 0438 894 265 info@colvendra.it
Collodel Milea Via Mire 7 31020 San Pietro di Feletto (TV) t/ 348 14 03 579 bigjump65@gmail.com
Collodel Paola
Via dei Colli 93/A 31015 Conegliano (TV) t/ 347 48 41 401 paolacollodel@virgilio.it
Compagnia del Vino Via S. Vito di Sotto - Loc. Calzaiolo 50026 S. Casciano Val di Pesa (FI) t/ 055 243 101 info@compagniadelvino.it
Conte Collalto
Via XXIV Maggio 1 31058 Susegana (TV) t/ 0438 435 811 info@cantine-collalto.it
Conte Loredan Gasparini Via Martignago Alto 23 - Venegazzù 31040 Volpago del Montello (TV) t/ 0423 621 658 info@loredangasparini.it
Corrazin
Via Scandolera 46 31020 Vidor (TV) t/ 0423 985 100 info@proseccocorazzin.com
Cosmo
Via Giardino 94 - Carpesica 31029 Vittorio Veneto (TV) t/ 0438 920 025 info@bellenda.it
Costa Via Canal Nuovo 57 - Col S. Martino 31010 Farra di Soligo (TV) t/ 0438 989 552 fajon@hotmail.it
Costabella Via Giunti 27 31015 Conegliano (TV) t/ 0438 62405 soc.agr.costabella@gmail.com
Da Dalt Wilma Via Borgo America 9 31020 San Pietro di Feletto (TV) t/ 340 31 44 276 wdadalt14@gmail.com
Da Sacco Dott. Alberto Via Piave 32 31020 Vidor (TV) t/ 0423 976 180
Da Soller Silvana Via Maset 1 - Rolle 31030 Cison di Valmarino (TV) t/ 0438 856 83 silvanadasoller@gmail.com
Dal Col Via F. Fabbri 87 - Solighetto 31053 Pieve di Soligo (TV) t/ 0438 826 94 renatodalcol@alice.it
Dal Din Via Montegrappa 29 31020 Vidor (TV) t/ 0423 987295 daldin@daldin.it
Dalla Libera
Via Val 20 - Funer 31049 Valdobbiadene (TV) 0423 975266 ss.dallalibera@gmail.com
Damuzzo Gianbattista
Via Canal Nuovo 103 - Col S. Martino 31010 Farra di Soligo (TV) t/ 0438 989358 damuzzogianbattista@libero.it
De Faveri Via G. Sartori 21 31020 Vidor (TV) t/ 0423 987 673 info@defaverispumanti.it
De Riz Luca Via Pianale 72/A 31020 San Pietro di Feletto (TV) t/ 0438 784 115 info@proseccoderiz.it
De Rosso Narciso Via S. Luca 36 - Colfosco 31030 Susegana (TV) t/ 0438 780 108
De Vallier Cristian Via Battistella 16 31053 Pieve di Soligo (TV) t/ 0438 980 500 info@studiodevallier.it
Dea
Eredi Bortolomiol Giuliano
Via G. Garibaldi 142 31049 Valdobbiadene (TV) giuliana@bortolomiol.com
Eredi Giancarlo Stiz
Via Veneto 44 31020 San Pietro di Feletto (TV) t/ 0422 579 779 m.stiz@mscorporate.it
Famiglia Scottà Via F. Fabbri 150 - Solighetto 31053 Pieve di Soligo (TV) t/ 0438 830 75 info@cantinascotta.it
Fasol Menin
Via Fasol Menin 22/B 31049 Valdobbiadene (TV) t/ 0423 974 262 myprosecco@fasolmenin.com
Fiorin Silvia Via Del Piantaletto 19 31053 Pieve di Soligo (TV) t/ 349 454 80 85 fiorinsilvia@libero.it
Follador Via Gravette 42 31010 Farra di Soligo (TV) t/ 0438 898 222 info@folladorprosecco.com
Frozza
Via Martiri 31 - Colbertaldo 31020 Vidor (TV) t/ 0423 987 069 valdobbiadene@frozza.it
Frozza Antonella Via Marzolle 3 31030 Cison di Valmarino (TV) t/ 0438 856 92
Frozza Daniela Via Fontanafredda 17 Zuel di Qua 31030 Cison di Valmarino (TV) t/ 0438 857 84
Furlan Vicolo Saccon 48 31020 San Vendemiano (TV) t/ 0438 778 267 info@furlanvini.com
Gallina Claudio Via Cavarie 8 31049 Valdobbiadene (TV) t/ 0423 982 071 az.gallinaclaudio@gmail.com
Gallon Severino Via G. Lorenzoni 1/A 31030 Cison di Valmarino (TV) t/ 0438 856 88 angelonardi88@gmail.com
Vicolo Longher 3 - Bigolino 31049 Valdobbiadene (TV) t/ 0423 971 017 info@dearivalta.it
Diotisalvi Via Guido Rossa 7 31058 Susegana (TV) t/ 0423 973 971 commerciale@domus-picta.com
Domus-Picta Via Arcol 51 31049 Valdobbiadene (TV) t/ 0438 270 74 info@diotisalvi.it
Dorigo Silvano Via Borgo San Michele 18 31010 Farra di Soligo (TV) t/ 347 33 01 780 cinziaesilvano@alice.it
Dotta Andrea Via Federa 1/A 31020 Refrontolo (TV) t/ 346 633 22 88 info@cantinadotta.it
Drusian
Via Anche 1 - Bigolino 31049 Valdobbiadene (TV) t/ 0423 982 151 drusian@drusian.it
Duca Di Dolle Via Piai Orientali 5 - Rolle 31030 Cison di Valmarino (TV) t/ 0438 975 809 a.baccini@ducadidolle.it
Follador Francesco Via Vettorazzi E Bisol, 61/A 31049 Valdobbiadene (TV) t/ 349 754 33 60 francescofollador@yahoo.it
Follador Gottardo Via Tridich 6 - Santo Stefano 31049 Valdobbiadene (TV) t/ 0423 900 253
Follador Santo Via Follo 43 - Santo Stefano 31049 Valdobbiadene (TV) t/ 0423 901 045
Foss Marai Via Strada di Guia 73 - Guia 31049 Valdobbiadene (TV) t/ 0423 900 560 info@fossmarai.it
Frassinelli Gianluca Via Della Vittoria 7 31010 Mareno di Piave (TV) t/ 0438 30 119 info@frassinelli.it
Fratelli Collavo Via Fossetta 4 31049 Valdobbiadene (TV) t/ 333 58 240 47 info@fratellicollavo.com
Fratelli Gatto Cavalier Via Cartizze 1 31049 Valdobbiadene (TV) t/ 0423 985 338 info@fratelligattocavalier.it
Gallon Vincenzo Via Enotria 23/A 31030 Cison di Valmarino (TV) t/ 0438 857 52 alessandrogallon@libero.it
Garbara Via Menegazzi 19 - S. Stefano 31049 Valdobbiadene (TV) t/ 0423 900 155 info@garbara.it
Gemin Via Erizzo 187 31049 Valdobbiadene (TV) t/ 0423 975 450 info@spumantigemin.it
Gli Allori Via E. Fenzi 10 31015 Conegliano (TV) info@gliallori.eu ―
Gregoletto
Via S. Martino 83 - Premaor 31050 Miane (TV) t/ 0438 970 463 Info@Gregoletto.com
Guia
Via Fontanazze 2/A - Guia 31049 Valdobbiadene (TV) t/ 0423 900 421 info@aziendaagricolaguia.com
Hausbrandt Trieste 1892 Via Barriera 41 31058 Susegana (TV) t/ 0438 644 68 info@colsandago.it
47 46
SOCI CONSORZIO CONEGLIANO VALDOBBIADENE PROSECCO DOCG
SOCI CONSORZIO CONEGLIANO VALDOBBIADENE PROSECCO DOCG
I Bamboi
Via Brandolini 13
31020 San Pietro di Feletto (TV) t/ 0438 787 038 ibamboi@tmn.it
Il Colle
Via Colle 15 31020 San Pietro di Feletto (TV) t/ 0438 486 926 info@proseccoilcolle.it
Il Follo Via Follo 36 - Santo Stefano 31049 Valdobbiadene (TV) t/ 0423 901 092 info@ilfollo.it
Istituto Tecnico Agrario Cerletti
Via XXVIII Aprile 20 31015 Conegliano (TV) t/ 0438 614 21 tvis00800e@istruzione.it
Latentia Winery
Via Martiri delle Foibe 12-16-18 31015 Conegliano (TV) t/ 0438 39 879 info@latentiawinery.com
La Casa Vecchia
Via Callonga 12 - Santo Stefano 31049 Valdobbiadene (TV) t/ 0423 900 455 info@lacasavecchia.it
La Castella
Via Veneto 7/7 31010 Mareno di Piave t/ 331 90 51 571 la.castella@libero.it
La Farra Via San Francesco 44 31010 Farra di Soligo (TV) t/ 0438 801 242 info@lafarra.it
La Marca Via Baite 14 31046 Oderzo (TV) t/ 0422 814681 lamarca@lamarca.it
La Rivetta Via Erizzo 107 31035 Crocetta del Montello t/ 0423 86 07 info@villasandi.it
La Svolta
Via Condel 1 31020 San Pietro di Feletto (TV) t/ 0438 784 251 info@proseccolasvolta.it
La Tordera
Via Alnè Bosco 23 31020 Vidor (TV) t/ 0423 985 362 info@latordera.it
La Vigna di Sarah
Via del Bersagliere 30/A 31029 Vittorio Veneto (TV) t/ 340 600 34 42 info@lavignadisarah.it
L’Antica Quercia
Via Cal di Sopra 8 - Scomigo 31015 Conegliano (TV) t/ 0438 789 344 info@anticaquercia.it
Le Bertole
Via Europa 2 31049 Valdobbiadene (TV) t/ 0423 975 332 info@lebertole.it
Le Colture
Via Follo 5 - Santo Stefano 31049 Valdobbiadene (TV) t/ 0423 900 192 info@lecolture.it
Le Contesse
Via Cadorna 39 - Tezze 31020 Vazzola (TV) t/ 0438 28795 lecontesse@lecontesse.it
Le Manzane
Via Maset 47/B 31020 San Pietro di Feletto (TV) t/ 0438 486606 info@lemanzane.it
Le Masiere Via Strada Nuova Grave 7 31049 VALDOBBIADENE TV t/ 339 6399183 giampaolo.miotto@alice.it
Le Mire Via Mire 32 31020 Refrontolo (TV) t/ 333 95 44 354 lemireliessi@gmail.com
Le Rive de Nadal Via dei Cavai 42 31010 Farra di Soligo (TV) t/ 0438 801315 info@lerivedenadal.com
Le Rive di Bellussi Luisa Francesca
Via Rive 10 - Colbertaldo 31020 Vidor (TV) t/ 0423 986 020 lerivebellussiluisa@tiscali.it
Le Rughe Via Papa Giovanni XXIII 24 31015 Conegliano (TV) t/ 0434 75033 info@proseccolerughe.com
Le Volpere Via Ugo Cecconi 13 31010 Farra di Soligo (TV) t/ 0438 801 204 info@levolpere.it
Le Zulle Via San Rocco 10/2 31010 Farra di Soligo (TV) t/ 0438 801 011
Lucchetta
Via Calpena 38 31015 Conegliano (TV) t/ 0438 325 64 info@lucchettavini.com
Maccari Via Colombo 19 31015 Conegliano (TV) t/ 0438 400 350 spumanti@maccarivini.it
Malibran
Via Barca II 63 31058 Susegana (TV) t/ 0438 781 410 info@malibranvini.it
Mani Sagge
Via Manzana 46 31020 San Pietro di Feletto (TV) t/ 0438 155 0148 info@manisagge.com
Marchiori Via del Sole 1 31010 Farra di Soligo (TV) t/ 0438 801 333 info@marchioriwines.com
Marcon Annamaria Via Case Marcon 31029 Vittorio Veneto (TV) t/ 347 8941264 cais.stefania@hotmail.it
Marcon Levis
Via Credazzo 38-B 31010 Farra di Soligo (TV) t/ 0438 801 043
Marinelli Pietro Via San Gallet 23 31053 Pieve di Soligo (TV) t/ 335 61 76 740
Marsura Natale Strada Fontanazze 4 31049 Valdobbiadene (TV) t/ 0423 901 054 info@marsuraspumanti.it
Marsuret Via Barch 17 - Guia 31049 Valdobbiadene (TV) t/ 0423 900 139 marsuret@marsuret.it
Martignago Annalisa
Via San Lorenzo 1 31010 Farra di Soligo (TV) t/ 0438 801 828 annalisa.martignago@libero.it
Masottina
Via Custoza 2 31015 Conegliano (TV) t/ 0438 400 775 info@masottina.it
Mass Bianchet
Via Soprapiana 42 - Colbertaldo 31020 Vidor (TV) t/ 0423 987 427 info@massbianchet.com
Meneguz
Via Ghette 13 - Corbanese 31010 Tarzo (TV) t/ 338 94 54 185 info@vinimeneguzsara.it
Merotto
Via Scandolera 21 - Col S. Martin 31010 Farra di Soligo (TV) t/ 0438 989 000 merotto@merotto.it
Merotto Dino Località Case Sperse 1 31030 Cison di Valmarino (TV) t/ 334 31 66 459
Merotto Giuseppe
Via Castelletto 2 - Col S. Martino 31010 Farra di Soligo (TV) t/ 0438 989 053
Mionetto
Via Colderove 2 31049 Valdobbiadene (TV) t/ 0423 97 07 info@mionetto.it
Miotto
Via Scandolera 24 - Colbertaldo 31020 Vidor (TV) t/ 0423 985 095 info@cantinamiotto.it
Miotto Fiori
Via Callonga 9 - S. Stefano 31049 Valdobbiadene (TV) t/ 0423 900 349
Moncader Casale Moncader 13 - Combai 31050 Miane (TV) t/ 0438 989 143 info@moncader.it
Mongarda
Via Canal Nuovo 8 - C.S.Martin 31010 Farra di Soligo (TV) t/ 0438 989 168 info@mongarda.it
Montesel
Via San Daniele 42 - Colfosco 31058 Susegana (TV) t/ 0438 781 341 info@monteselvini.it
Moret
Via Condel 2 31020 San Pietro di Feletto (TV) t/ 340 08 39 642 info@moretvini.it
Moro Sergio
Via Crede 10 - Col S. Martino 31010 Farra di Soligo (TV) t/ 0438 898 381 info@morosergio.it
Nani Rizzi
Via Stanghe 22 - Guia 31049 Valdobbiadene (TV) t/ 0423 900 645 info@nanirizzi.it
Nardi Giordano
Via Piave - Soligo 31010 Farra di Soligo (TV) t/ 0438 82 458 info@nardigiordano.com
Nino
Via Garibaldi 14 31049 Valdobbiadene (TV) t/ 0423 972 051 info@ninofranco.it
Pase Michele
Via Casale 7/A 31020 Refrontolo (TV) t/ 349 75 03 800 michelepase@libero.it
Pastrolin Giulietta
Via San Michele 35 31020 San Pietro di Feletto (TV) t/ 366 50 73 627 pierangelo.sartori61@gmail.com
Pederiva Mariangela
Via Cal del Grot 1/1 - Guia 31049 Valdobbiadene (TV) t/ 0423 900 143 info@spumantipederiva.com
Perlage Cal del Muner 16 - Soligo 31010 Farra di Soligo (TV) t/ 0438 900 203 info@perlagewines.com
Piccolin
Via Roma 45/B 31049 Valdobbiadene (TV) t/ 334 54 59 777 spumantipiccolin@gmail.com
Prapian
Via Arfanta 9 - Località Prapian 31020 Tarzo (TV) t/ 049 93 85 023 mail@sacchettovini.it
Pra dell'Ort Via Garibaldi 333 31049 Valdobbiadene (TV) t/ 0423 975 450 info@spumantigemin.it
Prima Vera Via Pra dell'orto 6/P 31049 Valdobbiadene (TV) t/ 338 70 72 431 agricoleprima.vera@gmail.com
Rebuli Angelo e Figli
Via Strada Nuova di Saccol 40 31049 Valdobbiadene (TV) t/ 0423 973 307 info@rebuli.it
Resera Alberto
Via Enotria 7 - Rolle 31030 Cison di Valmarino (TV) t/ 0438 857 61 andreetta@andreetta.it
Riccardo
Via Cieca D’Alnè 4 31020 Vidor (TV) t/ 0423 985 248 info@proseccoriccardo.com
Riva dei Frati
Via del Commercio 31 31041 Cornuda (TV) t/ 0423 639 798 info@rivadeifrati.it
Riva Granda
Via C. Vecchio 5/A - Col S. Martino 31010 Farra di Soligo (TV) t/ 0438 987 022 info@proseccorivagranda.it
Riva Marchetti
Via del Rocol 6 31020 San Pietro di Feletto (TV) t/ 0438 271 09 nicola.zanatta@gmail.com
Rizzi Francesca
Via Vernaz 46 31020 Refrontolo (TV) t/ 0438 894 149 francescarizzi@hotmail.com
Roccat Via Roccat e Ferrari 1 31049 Valdobbiadene (TV) t/ 0423 972839 info@roccat.it
Romani Facco Barbara Via Manzana 46 31029 Vittorio Veneto (TV) t/ 328 654 03 74 barbararomanifacco@gmail.com
Ronce
Via Verdi 42 - Col San Martino 31010 Farra di Soligo (TV) t/ 0438 898 417 roncevini@gmail.com
Ronfini Leonardo Via del Prosecco 7/A - C.S.Martino 31010 Farra di Soligo (TV) t/ 0438 989614 info@ronfini.com
Ruge Via Fosse 1 31049 Valdobbiadene (TV) t/ 329 95 12 493 info@ruge.it
Ruggeri Via Prà Fontana 4 31049 Valdobbiadene (TV) t/ 0423 90 92 ruggeri@ruggeri.it S.I.V.AG. Via Ongaresca 34 31020 San Fior (TV) t/ 0438 764 18 info@sivag.it
Salatin
Via Doge Alvise IV Mocenigo 31016 Cordignano (TV) t/ 0438 995 928 info@salatinvini.com
Sanfeletto
Via Borgo Antiga 39 31020 S. Pietro di Feletto (TV) t/ 0438 486 832 sanfeletto@sanfeletto.it
San Giovanni Via Manzana 4 31015 Conegliano (TV) t/ 0438 31598 vinisangiovanni@libero.it
San Giuseppe
Via Po 10/A 31020 San Pietro di Feletto (TV) t/ 0438 450526 vini.sangiuseppe@libero.it
San Gregorio Via San Gregorio 18 31049 Valdobbiadene (TV) t/ 0423 975 534 info@proseccosangregorio.it
San Rocco Loc. Musile, 2 31058 Susegana (TV) t/ 0438 435 287 segreteria@borgoluce.it
Santa Eurosia
Via della Cima 8 31049 Valdobbiadene (TV) t/ 0423 973 236 massimo@santaeurosia.it
Santa Margherita
Via Ita Marzotto 8 30025 Fossalta di Portogruaro (VE) t/ 0421 246 111 info@santamargherita.com
Santantoni
Via Cimitero 52 - Santo Stefano 31049 Valdobbiadene (TV) t/ 0423 900 226 info@santantoni.it
Scandolera Via Scandolera 95 - Colbertaldo 31020 Vidor (TV) t/ 0423 985 107 info@scandolera.it
Scarpel Vittorio Via Scandolera 43 31010 Farra di Soligo (TV) t/ 368 22 96 83
Serena Wines 1881 Via C. Bianchi 1 31015 Conegliano (TV) t/ 0438 20 11 info@serenawines.com
Serre Via Casale Vacca 8 - Combai 31050 Miane (TV) t/ 0438 893 502 info@proseccoserre.com
Sette Nardi
Via Borgo dei Faveri 26 31010 Farra di Soligo (TV) alessandra.marton@perlagewines.com
Silvano Follador
Via Callonga 11 31049 Valdobbiadene (TV) t/ 0423 900 295 info@silvanofollador.it
Simoni Diego Via San Rocco 30 31010 Farra di Soligo (TV) t/ 0438 801404 info@caberlata.it
Siro Merotto
Via Castelletto 88 31010 Farra di Soligo (TV) t/ 0438 989 156 info@siromerotto.it
Somasot
Via San Giacomo 2 31049 Valdobbiadene (TV) t/ 0423 980 523 info@sanzovo.it
Sommariva
Via Luciani 16/A - S. M. di Feletto 31020 San Pietro di Feletto (TV) t/ 0438 784 316 info@sommariva-vini.it
Sorelle Bronca
Via Martiri 20 - Colbertaldo 31020 Vidor (TV) t/ 0423 987 201 info@sorellebronca.com
Spagnol – Col del Sas Via Scandolera 51 - Colbertaldo 31020 Vidor (TV) t/ 0423 987 177 info@coldelsas.it
Sui Nui Via Cal Fontana 15/B 31049 Valdobbiadene (TV) t/ 0423 1916793 info@suinuispumanti.it
Tanoré
Via Mont 4 - S. Pietro di Barbozza 31049 Valdobbiadene (TV) t/ 0423 975 770 info@tanore.it
Tenuta 2 Castelli Via Cucco 23 31058 Susegana (TV) t/ 0422 832 336 info@2castelli.com
Tenuta degli Ultimi Via A. Diaz 18 31015 Conegliano (TV) t/ 0438 32 888 ultimo@degliultimi.it
Tenuta Guardian Via Mas e Chiodari 1 31049 Valdobbiadene (TV) t/ 349 30 86 898 tenutaguardian@hotmail.com
Tenuta Eliseo Via Marcorà 70 - Ogliano 31015 Conegliano (TV) t/ 0438 788 157 bianchi.fred@gmail.com
Tenuta Rivaluce Via Trieste 95 31038 Paese (TV) t/ 340 32 11 749 info@rivaluce.it
Tenuta Torre Zecchei Via Capitello Ferrari 1/3C 31049 Valdobbiadene (TV) t/ 0423 976 183 info@torrezecchei.it
49 48
Franco
SOCI CONSORZIO CONEGLIANO VALDOBBIADENE PROSECCO DOCG
SOCI CONSORZIO CONEGLIANO VALDOBBIADENE PROSECCO DOCG
Tenuta Villa Fiorita
Via San Michele 35
31020 San Pietro di Feletto (TV) t/ 0438 455 092
Tenute Lunelli
Via Del Ponte 15 38123 Trento (TN) t/ 348 102 42 87 l.scaravonati@gruppolunelli.it
Teot Guido
Viale Spellanzon 40 31015 Conegliano (TV) t/ 348 88 000 86 guido.teot@gmail.com
Terre Boscaratto
Via Ponte Vecchio 5/A 31058 Susegana (TV) t/ 0438 17 36 690 info@terreboscaratto.com
Terre di Ogliano
Via SS. Trinità 58 - Ogliano 31015 Conegliano (TV) t/ 0438 400 775 info@masottina.it
Terre di San Venanzio
Via Capitello Ferrari 1 31049 Valdobbiadene (TV) t/ 0423 974 083 info@terredisanvenanzio.it
Teruz Terra di Vite
Via Campagna, 2 31049 Valdobbiadene (TV) t/ 0423 982185 info@teruz.it
Titton Daniela
Via delle Caneve 8 - San Michele 31020 San Pietro di Feletto (TV) t/ 0438 613 66
Toffoli
Via Liberazione 26 31020 Refrontolo (TV) t/ 0438 978 204 toffoli@proseccotoffoli.it
Toffolin Adriana
Via Pian di Guarda 38 - Farrò 31051 Follina (TV) t/ 0438 970 880 bizstefano@gmail.com
Tomasi Gianfranco
Via Papa Luciani 2/A - Corbanese 31020 Tarzo (TV) t/ 339 60 46 096
Tonon
Via Carpesica 1 - Carpesica 31029 Vittorio Veneto (TV) t/ 0438 920 004 info@vinitonon.com
Tormena Angelo
Via Martiri della Liberazione 7 31020 Vidor (TV) t/ 0423 987 082 info@prosecco-tormena.it
Tormena F.lli
Via Roma 177 - Colbertaldo 31020 Vidor (TV) t/ 0423 987 623 info@tormenafratelli.it
Uvemaior
Via San Gallet 36 - Solighetto 31053 Pieve di Soligo (TV) t/ 348 52 55 070 info@uvemaior.it
Val De Cune
Via Spinade 41 - Guia 31049 Valdobbiadene (TV) t/ 0423 901 112 info@valdecune.it
Valdellovo
Via Cucco 29 - Collalto 31058 Susegana (TV) t/ 0438 981 232 info@valdellovo.it
Valdo
Via Foro Boario 20 31049 Valdobbiadene (TV) t/ 0423 90 90 info@valdo.com
Valdoc Sartori
Via Menegazzi 7 - Santo Stefano 31049 Valdobbiadene (TV) t/ 0423 900 278 info@valdocsartori.it
Varaschin Str. Chiesa 10 - S.P. di Barbozza 31049 Valdobbiadene (TV) t/ 0423 973 553 info@varaschin.com
Vazzoler
Via Damiano Chiesa 7 31015 Conegliano (TV) t/ 335 74 27 870 laura.vazzoler@vazzolervini.com
Vedova Valentina
Via dei Pianari 2/B 31049 Valdobbiadene (TV) t/ 338 87 08 660 info@agriturismovedova.it
Vedova Tarcisio
Via Case Vecchie 5 - Saccol 31049 Valdobbiadene (TV) t/ 0423 972 564 info@vedovatarcisio.it
Vettoretti Vinicio
Via Calmaor 44 - Bigolino 31030 Valdobbiadene (TV) t/ 0423 981 218 vinicio.vettoretti@gmail.com
Vettori Arturo
Via Borgo America 26 31020 San Pietro di Felletto (TV) t/ 0438 348 12 info@vinivettori.it

Vigne Alte
Via Fasol Menin 22/B 31049 Valdobbiadene (TV) t/ 0423 974 262 info@fasolmenin.it
Vigne Doro
Via Colombo Cristoforo 74 31015 Conegliano (TV) t/ 0438 410 108 info@vignedoro.it
Vigne Matte
Via Tea 8 - Località Rolle 31030 Cison di Valmarino (TV) t/ 0438 975 798 info@vignematte.it
Vigne Savie
Via Follo 26 - Santo Stefano 31049 Valdobbiadene (TV) t/ 0423 900 235 info@vignesavie.it
Vigneto Vecio Via Grave 8 - Santo Stefano 31049 Valdobbiadene (TV) t/ 0423 900 338 info@vignetovecio.it
Villa Maria Via San Francesco 15 31010 Farra di Soligo (TV) t/ 0438 801 121 info@villamaria-spumanti.it
Villa Sandi Via Erizzo 113/B 31035 Crocetta del Montello (TV) t/ 0423 86 07 info@villasandi.it
Vinicola Cide Via Liberazione 17 31010 Mareno di Piave (TV) t/ 0438 492 562 info@vinicide.it
Zamai Galileo
Via Casale Vacca 1 - Combai 31050 Miane (TV) t/ 0438 989 454 serena.zamai@gmail.com
Zanette Carlo
Via Puccini 25 - San Martino 31014 Colle Umberto (TV) t/ 0438 394 660 carlo.zanette@libero.it
Zanin Graziano Via Eirzzo 105 31049 Valdobbiadene (TV) t/ 0423 973 032 az.agric.zaningraziano@gmail.com
Zucchetto Paolo
Via Cima 16 - S. Pietro di Barbozza 31049 Valdobbiadene (TV) t/ 0423 972 311 sales@zucchetto.com
Trillyeast
Da sempre attenta alla tutela della salute pubblica e dell’ambiente, Bioenologia 2.0 ha ideato e prodotto un lievito innovativo che nasce dalla sinergica associazione di due ceppi unici ed esclusivi nel panorama enologico, isolati per la prima volta nel cuore di Valdobbiadene: la Kazachastania servazzii - un non cerevisiae che possiede una forte azione di biocontrollo – e la Pichia kluyveri – che “respira lo zucchero”, togliendo ossigeno alla flora indigena, e dunque “soffocando” i non Saccharomyces presenti naturalmente nel mosto.

Trillyeast conferisce tipicità al Prosecco, ne aumenta la durata, ha una capacità di pompa protonica molto elevata ed un ottimo effetto di biocontrollo. È superlativo nella sostituzione della solforosa.
Una volta inoculato, Trillyeast produce immediatamente una quantità esuberante di aromi fino a un massimo di 2 gradi alcool (24-48 ore): il profilo aromatico è eccezional mente elevato e genera, rispetto a tutti gli altri lieviti, da 15 a 28 volte la quantità dei composti aromatici della rosa, della pesca della pera e della mela.
Per completare la fermentazione si consiglia l’inoculo sequenziale di un Saccharomyces cerevisiae come Atecrem Rapsodia, lievito bayanus var. uvarum, isolato nella zona di Conegliano.

Trillyeast è un lievito con il quale siamo orgogliosi di affiancare l’enologo nella produ zione di vini unici, genuini, capaci di intersecarsi con le aspettative del consumatore. Un lievito fresco in crema, completamente naturale.
Bioenologia 2.0 Srl Via Verdi 32 31046 Oderzo (TV) www.bioenologia.com
51
luglio /2022 50
Conegliano Valdobbiadene
le
→
Aziende informano
SOCI CONSORZIO CONEGLIANO VALDOBBIADENE PROSECCO DOCG
Il lievito che esalta il Prosecco: ne aumenta i profumi e la durata, con effetto di biocontrollo
INDUSTRIA 4.0. Nella progettazione e realizzazione di linee complete, Fipal si è mossa su più fronti in ottica di Industria 4.0 introducendo per prima cosa la piattaforma M.E.S (Manufacturing Execution System), un sistema in grado di fornire in tempo reale le informazioni necessarie a controllare, gestire ed ottimizzare tutte le attività del processo produttivo. Questo è possibile farlo mediante vari step, in base all’architettura digitale che il cliente vuole installare all’interno del proprio reparto produttivo:



















• SUPERVISIONE PASSIVA: gestione dei dati base di produzione, interfaccia avviamento/conclusione produzione, raccolta dati dalla linea, visualizzazione dati RealTime tramite sinottici, analisi dei principali indici statistici ed elenco dei downtime.
• SUPERVISIONE ATTIVA: SUPERVISIONE PASSIVA + invio dei dati base di produzione alle macchine MASTER di blocco per una gestione bidirezionale dei dati di produzione. Questa interfaccia può permettere al sistema di interagire con le logiche di produzione.
• SUPERVISIONE GESTITA: SUPERVISIONE ATTIVA + sistema di interconnessione bidirezionale con gestionale cliente per la ricezione degli ordini di produzione (distinta base, …) ed il ritorno dei dati di produzione.
REALTÀ VIRTUALE. Un altro importante strumento introdotto è quello relativo alla realtà virtuale, che dà la possibilità al cliente di vedere realmente come sarà la linea all’interno dello stabilimento e soprattutto come funzionerà. Questo è un enorme vantaggio, perchè
possibili problemi. ASSISTENZA REMOTA. In ottica 4.0, Fipal si è mossa anche nella fase post vendita, seguendo il cliente anche dopo la messa in moto dell’impianto, monitorando l’effettiva funzionalità dei macchinari con l’assistenza remota. Questo strumento ha permesso ai tecnici Fipal di sorvegliare costantemente le macchine e avvisare per tempo il cliente di malfunzionamenti o condizioni di utilizzo non corrette. Un grande punto di forza perché il cliente non viene solo accompagnato durante la realizzazione del progetto, ma soprattutto nella fase successiva, quella che riguarderà l’effettiva funzionalità dell’impianto.
un’ottica
IDEAS GET TO LIFE linee di imbottigliamento “chiavi in mano” fino a 30.000 b/h campbelladv.com 18221A FIPAL - 43014 Felegara (Parma) Italy - Tel. +39 0525 431199 - Email: info@fipal.it www.fipal.it FIPAL FOCUS METTISEPARATORI CHIUDI CARTONI DEPALETTIZZATORI PALETTIZZATORI SISTEMI DI PREPARAZIONE STRATO INCARTONATRICI INCASSETTATRICI BAG IN BOX ISOLE ROBOTIZZATE MONOBLOCCHI DI CONFEZIONAMENTO DIVISORI BOTTIGLIE
progetto,
aiuta molto ad intraprendere determinate scelte in fase di stesura del
soprattutto in
di prevenzione di futuri
in stagione
TECNICHE E SOLUZIONI VITIVINICOLE

55 Conegliano Valdobbiadene luglio /2022
LUGLIO /2022 → L’alveare, una centralina ambientale perfetta Il progetto innovativo “Eno-Bee” → La viticoltura eroica in campo La prima edizione di “Vite in Campo” dedicata alla viticoltura eroica → Life-Atena: un trattore ibrido per la Denominazione I primi test in campo → La Flavescenza dorata della vite La più importante malattia infettiva della vite
a cura di Marta Battistella (Consorzio di Tutela del Vino Conegliano Valdobbiadene Prosecco) Leone Braggio e Roberto Merlo (Uva Sapiens S.r.l.)
Conegliano Valdobbiadene Redazione
L’alveare, una centralina ambientale perfetta
Al via il progetto innovativo “Eno-Bee” per identificare lo stato ambientale tramite lo studio di organismi adatti, come le api

Da qualche mese il Consorzio di Tutela del Conegliano Valdobbiadene Prosecco DOCG ha avviato un progetto in collaborazione con Enomarket per il progetto “Eno-Bee api in vigna”. Il bio-monitoraggio è una tecnica che permette di rilevare nell’ambiente il grado di inquinamento tramite lo studio di alcuni organismi particolarmente adatti. Anche la presenza di licheni e muschi ci consente di individuare aree più pulite rispetto ad altre solo verificandone l’esistenza o i tempi di accrescimento. L’interesse è ricaduto sull’unico sistema allevabile ancora definibile “selvatico”
l'alveare
Una centralina ambientale perfetta per questo scopo: le api sono sensibili alle materie inquinanti, risentono del contatto con esse e, fra i tanti problemi, la colonia non si sviluppa normalmente o si verificano spopolamenti o ancor peggio morie. Sono state scelte le api, proprio per poter verificare lo stato di salute del territorio nel modo geograficamente più ampio possibile. Sono state scelte perché sappiamo che ciò che le danneggia oggi si rifletterà nel nostro futuro. Sono state scelte perché ci hanno “stregato”
57 Conegliano Valdobbiadene luglio /2022 IN STAGIONE
Consorzio Agrario di Treviso e Belluno: giocare d’anticipo per il bene delle aziende agricole

La storia recente del Consorzio Agrario di Treviso e Belluno par la di riorganizzazione all’insegna dell’efficienza e della vicinanza alle aziende agricole del territorio. È ormai chiaro che il Consiglio direttivo agisce in questa direzione dimostrando grande coesio ne e volontà di lasciare un segno positivo. In queste settimane Giorgio Polegato è stato rinominato alla sua presidenza. A dargli man forte nella governance consortile, oltre ad un ottimo diret tivo, anche il direttore Antonio Maria Ciri che nell’ultimo biennio ha segnato un positivo cambio di passo.
Migliorarsi in tutte le fasi del mercato
“Quello che volevamo si realizzasse era dar vita ad un rap porto con i nostri clienti più snello e dinamico con grande atten zione alle dinamiche di mercato ed alle risposte da garantire ai nostrisocieclienticonladovutapuntualitàevelocità – racconta Polegato – Se vogliamo continuare ad essere una eccellenza dobbiamo migliorare, implementare, essere all’altezza in tutte le fasi della vendita. E sappiamo che l’assistenza al cliente è de terminante. A tal fine sono stati compiuti degli investimenti in termini di risorse umane inserendo anche delle nuove professio nalità, in modo da migliorare la nostra managerialità nei vari comparti del nostro Consorzio agrario”
A tal proposito è innegabile anche lo sforzo di miglioramento tecnologico che si sta compiendo per dotare gli uffici, i negozi ed magazzini di quella tecnologia indispensabile per il lavoro e lo scambio di informazioni. Guardando all’esterno è anche sotto gli occhi di tutti che la presenza a fiere e prove in campo si è svolta all’insegna di una immagine di qualità e adeguata alle migliori aspettative.
Una contingenza senza precedenti
Non mancano certo problemi che rendono unico questo pe riodo: “Gli aumenti delle materie prime, la lievitazione dei prezzi, la difficoltà di approvvigionamento e la crisi energetica sono la triste realtà – continua il presidente Polegato – Abbiamo fino ad oggi giocato d’anticipo riuscendo a non far mancare le forniture ai nostri clienti e cercando anche di limitare gli aumenti. Penso sia questa una delle funzioni di un consorzio e cioè tutelare gli agricoltori associati”
Lo studio
Nel 2018 Enomarket è riuscita a dimostrare che anche piccoli accorgimenti agronomici quali il sovescio, l’esclusione di de terminati principi attivi nella difesa fitosanitaria ed il rispetto di un determinato calendario di interventi, sono sufficienti a modificare determinate criticità e a far raggiungere quindi una discreta sinergia fra apicoltura e viticoltura, nel rispetto dell’ambiente in generale.
Un territorio collinare risulta estremamente vocato alla viti coltura e, a parere di Enomarket, può godere di ulteriore luce se in esso viene praticata una viticoltura compatibile con gli insetti pronubi. Il posizionamento di alveari, detti di monito raggio, posizionati a ridosso dei vigneti, consentono di capi re quanto i due mondi fossero strettamente interconnessi e potenzialmente compatibili; ciò è stato possibile procedendo con l’analisi dei parametri di controllo della moria, nonché della produzione del miele e dei derivati, come la cera, ad analisi chimiche per multi-parametro residuale.
I risultati ottenuti sono stati molto incoraggianti e da quel momento il progetto è quindi decollato. Nel rapporto tra vi ticoltori, di altre zone viticole, e apicoltura è stato chiesto ai produttori di condividere i loro interventi in vigneto (in parti colare quelli ritenuti più dannosi come gli insetticidi) al fine di poter rendere tutto compatibile con la vita delle api allevate (e non solo dei pronubi ovviamente). I viticoltori coinvolti si sono dimostrati attenti, rispettosi e corretti.
Il monitoraggio
Il progetto naturalmente è andato oltre e si è deciso quindi di installare delle bilance Melixa System suddivise in modo strategico sul territorio. Non una semplice bilancia ma uno strumento per controllare da remoto, in maniera facile ed efficace, tutto l’ecosistema che ruota attorno all’alveare: il sistema è in grado di fornire informazioni per verificare lo stato di salute e la produttività delle api nell’ambiente in cui sono state inserite, inoltre rileva e memorizza le informazio ni sul tempo, sul meteo, ed altre informazioni proprie dell’al veare, come ad esempio temperatura e umidità relativa.
"Eno Bee" è uno strumento utile a tutelare, sensibilizzare, valorizzare e comunicare un territorio e certi valori come salubrità e sicurezza di un certo ambiente. L’ape stessa è garante dello stato di salute dell’ambiente che la circonda, fornendo un’opportunità per dimostrare la sostenibilità delle aziende e dare un concreto valore aggiunto al vino che nasce in quei vigneti.


59 Conegliano Valdobbiadene luglio /2022 58 Conegliano Valdobbiadene luglio /2022 IN STAGIONE
→ le Aziende informano
www.consorzioagrariotreviso.it
Giorgio Polegato
Presidente Consorzio Agrario di Treviso e Belluno
Il Consorzio si sta rivelando uno straordinario ammortizzatore in tempo di crisi
La viticoltura eroica in campo
A luglio si è tenuta la prima edizione di “Vite in Campo”, dedicata alla viticoltura eroica, con eventi tra i filari e convegni a tema

Le colline del Conegliano Valdobbiadene Prosecco Superiore DOCG si caratterizzano da sempre per una particolarità: la presenza indiscussa della viticoltura eroica, una viticoltura che contempla un grande sforzo da parte dei produttori e da parte della stessa vite, a causa della conformazione morfologica dei terreni in cui si trova (ripide pendenze).
Il Consorzio di Tutela del Vino Conegliano Valdobbiadene Prosecco si pone, tra suoi obiettivi, quello di valorizzare al meglio il suo territorio e la sua tipica viticoltura, che vanta una storia e tradizione che si tramanda da molte generazioni. È per questo motivo che nel 2022 si è voluto fare un ulteriore passo in avanti e, grazie alla collaborazione con Condifesa Treviso e Belluno e le Edizioni L’Informatore Agrario, è stata organizzata un’edizione speciale di Vite in Campo con focus sulla viticoltura eroica. Vite in Campo è una manifestazione che pone l’attenzione sulle innovazioni di sistemi, delle macchine e delle attrezzature per una viticoltura sostenibile.
61 Conegliano Valdobbiadene luglio /2022 IN STAGIONE
La 1ª edizione di “Vite in Campo – Eroica” si è tenuta lo scor so 22 e 23 luglio a Col San Martino di Farra di Soligo, presso l’Azienda Agricola Merotto Graziano, con una grande presen za e partecipazione da parte dei viticoltori e appassionati del settore. Quest’edizione è stata dedicata in maniera esclusiva alle soluzioni e alle tecnologie per la gestione della vite in condizioni di forte pendenza, dove le tradizionali macchine agricole non sono in grado di arrivare.





L’evento tra i filari
L’evento, che prende parte in uno dei contesti viticoli più invi diati a livello mondiale, riconosciuto Patrimonio dell’Umanità UNESCO nel luglio 2019, si è focalizzato in modo particolare su macchine, attrezzature e sistemi per:
• Lavorazioni meccaniche in condizioni di elevata pendenza, anche oltre il 30%, con particolare riferimento alla difesa fi tosanitaria e alla gestione attenta del sottofila.
• Irrigazione di soccorso in aree declivi in modo da garantire le produzioni anche nelle annate siccitose, come quella che stiamo vivendo nel 2022.

• Difesa dalle avversità atmosferiche come gelo, vento ed eventi grandinigeni, che si registrano con sempre maggior frequenza a causa del cambiamento climatico.
• Difesa dalle fitopatie che possono compromettere i vigneti soprattutto in area collinare, come la Flavescenza dorata (che quest’anno ha avuto un’esplosione particolarmente si gnificativa) e mal dell’esca;
• Controllo dei danni causati dalla fauna selvatica (cinghiali, cervi, caprioli…)
• Innovazioni, frutto di accurata ricerca e sperimentazione, atte a rafforzare la sostenibilità ambientale, sociale ed eco nomica della viticoltura collinare.
I convegni a tema
Per dare ancora maggiore rilevanza all’iniziativa, oltre alle dimostrazioni in campo di cui si parlava precedentemente, è stato dato anche spazio per l’organizzazione di due conve gni sul tema. Il primo convegno si è tenuto il 14 luglio pres so l’Auditorium Santo Stefano a Farra di Soligo e ha avuto come tema le sistemazioni idraulico agrarie per la tutela e lo sviluppo del sito UNESCO “Colline del Prosecco di Coneglia no e Valdobbiadene”. Con relatori Marina Montedoro, Paolo Tarolli, Gino Lucchetta e Francesco Facchinato. Il secondo convegno si è invece svolto il 22 luglio presso l’Asilo Parroc chiale di Col San Martino e ha avuto come tematica i droni e la loro strategia di utilizzo in viticoltura, al fine di contrastare le emergenze sanitarie in vigna.
63 Conegliano Valdobbiadene luglio /2022 IN STAGIONE
CONVEGNO 14 luglio - Ore 20:00 SISTEMAZIONI IDRAULICO AGRARIE PER LA TUTELA E SVILUPPO DEL SITO UNESCO L’EVENTO SI TERRÀ PRESSO Auditorium Santo Stefano a Farra di Soligo Via Cal Nova, 16, 31010 Farra di Soligo TV Relatori: Prof. Paolo Tarolli, Dott. Gino Lucchetta, Ing. Francesco Facchinato Durante l’evento saranno affrontati seguenti temi: Importanza di mantenere in piena efficienza vigneti anche attraverso interventi di sistemazione idraulico agraria (miglior accesso dei mezzi meccanici; miglior regimazione delle acque anche attraverso la creazione di microinvasi) che age volino l’attività dei viticoltori nel pieno rispetto della tradizione paesaggistica del Patrimonio Unesco. Ottimizzare le sistemazioni idraulico agrarie in collina per una maggiore resilienza del vigneto al cambiamento climatico: esperienze dall’Italia e dal mondo Esempi concreti di intervento nelle colline Unesco. Il consolidamento dei muretti a secco. ORGANIZZATO DA MEDIA PARTNER SPONSOR
ASPETTANDO
Life-Atena: un trattore ibrido per la Denominazione
foto di Beatrice Pilotto
Un progetto triennale nato in collaborazione con la Antonio Carraro Spa, per realizzare un trattore specializzato compatto per vigneto e frutteto ibrido Plug-in. Al via i primi test in campo
Nel mese di novembre 2021 il Consorzio di Tutela del Vino Conegliano Valdobbiadene Prosecco DOCG è stato contattato da Antonio Carraro Spa, storica azienda veneta sita a Campodarsego, in provincia di Padova, fondata nel 1910 da Giovanni Carraro e oggi azienda leader mondiale nella produzione di trattori compatti per l’agricoltura specializzata e per il settore civile. La Carraro si pone a pieno titolo nel filone del New Green Deal promosso dall’Unione Europea accogliendo la nuova sfida lanciata per le macchine agricole di ridurre le emissioni di CO2 e rendere le macchine maggiormente sostenibili. L’azienda intende quindi sfruttare le tecnologie di elettrificazione disponibili al momento, trasformando il trattore con motore termico in trattore con motore ibrido (termico + elettrico).

65 Conegliano Valdobbiadene luglio /2022
IN STAGIONE
Il progetto E-tractor
Il motivo dell’incontro stava nella possibilità di instaurare una collaborazione tra la Carraro, il Consorzio di Tutela e al tre due realtà in un progetto (inizialmente identificato con il nome di “E-Tractor”), che prevedeva lo studio e la realizzazione di un trattore specializzato compatto per vigneto e frutteto ibrido Plug-in corredato di attrezzature a funziona mento totalmente elettrico in grado di lavorare in condizioni estreme con significativo risparmio di CO2 (> 25% rispetto alle attuali condizioni).
Mediante il trasferimento tecnologico la società vuole speri mentare l’impiego delle migliori tecnologie avanzate ad oggi disponibili per altri campi nel settore agricolo specializzato, dove risultano tuttora sconosciute e/o non applicate.
Non esiste ancora sul mercato un trattore isodiametrico ibri do per lavoro in vigneto e frutteto in condizioni estreme con corredo di attrezzature a funzionamento totale elettrico.
Il team di “Life-Atena”
Nello scorso inverno la Carraro ha quindi predisposto uno studio di fattibilità che prevedeva la creazione di un team di progetto multidisciplinare volto alla valutazione di potenzia li finanziamenti europei, in ambito LIFE (Programme for the Environment and Climate Action).

Il progetto, a cui è stato dato il nuovo nome di LIFE-ATENA, ha superato la fase di valutazione da parte della commis sione di esperti nel corso del mese di maggio 2022 con esito positivo. Al progetto collaborano attivamente diverse realtà, oltre al leader partner Antonio Carraro Spa.
ECOTHEA SRL – Innovativa start-up dell’Università Politecnico di Torino
Nel progetto ricopre i seguenti ruoli:
• Responsabile nella definizione dei protocolli e dell’ingegnerizzazione del propulsore ibrido e totalmente elettrico per il trattore.
• Attività di supporto nella costruzione dei prototipi e delle attività di dimostrazione in campo.
• Responsabile per il monitoraggio degli impatti.
I test in campo
Per le attività dimostrative in campo sono state indivi duate dal Consorzio di Tutela del Vino Conegliano Val dobbiadene Prosecco tre aree principali, all’interno della propria Denominazione:
→ Area 1 – compresa tra i Comuni di Pieve di Soligo, Farra di Soligo e Miane, caratterizzata da un’elevata pendenza
→ Area 2 – compresa tra i Comuni di San Pietro di Feletto e Refrontolo, caratterizzata da una media pendenza
→ Area 3 – compresa tra Conegliano e Ogliano, caratterizzata da pendenze più dolci
Sono state inoltre raccolte delle manifestazioni di inte resse da parte di alcune aziende ricadenti nelle aree so pra specificate, al fine di poter individuare con maggiore precisione i siti dove effettuare le future dimostrazioni in campo. Un valido contributo alla stesura del progetto è stato dato dalla società WarrantHub, che si è occupa ta della redazione di tutti i documenti nelle tempistiche previste. Al momento si sta procedendo nella definizione degli ultimi passaggi, di modo da poter cominciare ope rativamente il progetto, che avrà una durata di 3 anni (36 mesi). Per saperne di più, non vi resta che continuare a seguire le nostre attività!
• Supporto nella pianificazione della sostenibilità, nella replica e nello sfruttamento, e nelle attività di comunicazione e divulgazione.
ERO GMBH – Azienda tedesca leader nel mercato come produttore per la viticoltura
ERO è in grado di fornire macchine per tutte le fasi della sta gione (pre-potatura, legatura, defogliazione, cimatura, ecc.).
Nel progetto ricopre i seguenti ruoli:
• Responsabile di compiti relativi alla progettazione, costruzione e collaudo al banco delle attrezzature azionate elettricamente.
• Supporto nelle attività di dimostrazione in campo, pianificazione della sostenibilità, della replica e dello sfruttamento, e monitoraggio degli impatti.
• Contribuire alla valutazione dell’impatto e alle attività di divulgazione e comunicazione.
CONSORZIO DI TUTELA DEL VINO CONEGLIANO VALDOBBIADENE PROSECCO
Ente privato di interesse pubblico che raggruppa tutte le ca tegorie di produttori: viticoltori, vinificatori e imbottigliatori.
Nel progetto ricopre i seguenti ruoli:
• Responsabile di attività di comunicazione e divulgazione.
• Supportare il networking con produttori dei siti dimostrativi per una corretta implementazione delle attività dimostrative in campo.
• Supporto nella pianificazione della sostenibilità, della replica e dello sfruttamento e nel monitoraggio dell’impatto.
67 66 Conegliano Valdobbiadene luglio /2022 IN STAGIONE
La Flavescenza dorata della vite
È la più importante malattia infettiva della vite, con epidemie sempre più diffuse. Si combatte solo con strategie preventive
La Flavescenza dorata è una grave malattia infettiva epidemica della vite, causata da particolari batteri, chiamati fitoplasmi. Fu scoperta per la prima volta verso la metà degli anni ’50 in Francia e da quel momento si è diffusa dapprima pian piano, poi velocemente in moltissime aree vitate europee, inclusa l’Italia. Le primissime segnalazioni in territorio italiano risalgono ai primi anni ’70, precisamente nell’Oltrepò Pavese.
La malattia si è però manifestata in modo diffuso e con ricadute economicamente importanti soltanto agli inizi degli anni Novanta, sulle produzioni vitivinicole del Veneto in particolar modo.

69 Conegliano Valdobbiadene luglio /2022 IN STAGIONE
La cicalina






Il principale insetto vettore del fitoplasma è la cicalina di ori gina americana Scaphoideus titanus instauratasi in Europa all’inizio del XX secolo. Scaphoideus titanus compie una sola generazione all’anno. Generalmente, alle nostre latitudini, le prime uova dell’insetto schiudono verso metà maggio, ma le schiuse proseguono poi nell’arco di tutto il successivo mese di giugno. Seguono 5 stadi larvali, sprovvisti di ali, ed infine lo stadio adulto alato, dopo circa 1 mese e mezzo dalla nascita.




Risulta di fondamentale importanza sorvegliare lo sviluppo e quantificare la presenza dell’insetto ai fini di una lotta ragio nata, per posizionare i trattamenti nel momento più opportu no e verificarne l’efficienza.



Le osservazioni delle forme giovanili dell’insetto vanno ese guite sui polloni fra metà maggio e giugno. Gli adulti invece, essendo dotati di maggior capacità di spostamento grazie alla presenza delle ali, vanno monitorati attraverso l’utilizzo di trappole cromotropiche gialle rivestite di colla, con cambio ogni 15 giorni fino a settembre.
La epidemie
Tenuto conto dell’epidemiologia, del potenziale di dannosità in termini economici e dell’impossibilità di contrastarne to talmente la diffusione, la Flavescenza dorata e il suo insetto vettore sono classificati organismi di quarantena per l’Unio ne Europea, da cui derivano obblighi di prevenzione e control lo per tutti i Paesi membri.

Nelle ultime annate in Veneto (ma non solo) le manifestazio ni epidemiche causate dalla Flavescenza dorata, e dai gial lumi della vite in generale, hanno assunto dimensioni con siderevoli e sempre più preoccupanti interessando gli areali viticoli soprattutto nelle province di Treviso, Vicenza, Venezia e in parte di quella di Verona. Per questo motivo, nel 2022 la Regione del Veneto, con il Decreto n. 30 del 12 maggio 2022, ha disposto quanto segue:

→ Nell’intero territorio delle province di Treviso e Vicenza, nelle aree DOC “Lison-Pramaggiore” e “Piave” in provincia di Venezia, nelle aree DOC “Soave”, “Durello” e “Arcole” in pro vincia di Verona:
• Obbligo di due interventi insetticidi negli impianti coltivati con metodo convenzionale/integrato, il primo da farsi nel periodo in cui sono presenti, in prevalenza, le forme giova nili di terza età, il secondo in quello in cui sono prevalenti le quarte età;


• Obbligo di tre interventi insetticidi nei vigneti coltivati con metodo biologico, di cui al Reg. CE 834/2007, a partire dal periodo in cui sono presenti, in prevalenza, le forme giova nili di seconda età, a distanza di 7-10 giorni l’uno dall’altro.

La prevenzione e la lotta
La lotta alla malattia è solamente di tipo preventivo: 1 – Diagnosi precoce e rapida delle viti sospette
Monitoraggio dell’insetto vettore 3

Trattamenti insetticidi nei confronti dell’insetto vettore 4 – Estirpo e/o capitozzatura delle viti infette

Oggi le perdite di produzione e le morie delle piante ricor dano le situazioni epidemiche dei primi anni ’90. Le cause di questi fenomeni possono ricondursi al cambiamento clima tico in atto, caratterizzato sempre più da sbalzi termici e re pentini cambiamenti, ma anche alla sospensione dei principi insetticidi utilizzabili per la lotta a Scaphoideus titanus Riguardo al vettore, molti studi hanno dimostrato che gli adulti sono in grado di acquisire i fitoplasmi e di completare la latenza diventando infettivi in circa 2 settimane.
Dal punto di vista epidemiologico, questa capacità di tra smettere la malattia si traduce in un elevato potenziale d’in fezione da parte degli adulti provenienti dai vigneti limitrofi non trattati e quindi con viti infette che fungono da inoculo. Se andiamo ad analizzare le strategie di contenimento del vettore, rispetto a 20 anni fa, gli insetticidi attualmente uti lizzabili sono attivi su singoli fitofagi della vite, conseguen temente la lotta contro le tignole o le cocciniglie della vite non ha nessun effetto collaterale nei confronti della cicalina. Inoltre, le molecole registrate contro lo Scaphoideus titanus hanno una bassa classe tossicologica e ciò comporta spesso risultati non soddisfacenti, inoltre l’efficacia è fortemente influenzata dalle condizioni tecnico – agronomiche dei vigneti e dalle modalità di applicazione (ad esempio, bisogna utiliz zare ampi volumi d’acqua se si vuole incrementare l’efficacia del trattamento stesso).
Un’ulteriore complicazione è data dalla limitata disponibili tà di sostanze attive persistenti (risale al 2021 l’eliminazio ne dell’indoxacarb, per citarne uno, ma negli anni precedenti sono stati revocati anche il thiamethoxam e il buprofezin), che rende difficoltoso il contenimento degli esemplari adulti provenienti dall’esterno.
Nei vigneti a conduzione biologica queste limitazioni vengono accentuate dal fatto che le sostanze attive utilizzabili sono fotolabili e quindi il trattamento deve essere eseguito esclu sivamente nelle ore notturne.
Al fine di pianificare adeguate strategie di contenimento del vettore sono necessarie informazioni relative alla reale ef ficacia delle attuali sostanze attive disponibili sul mercato e ammesse in viticoltura, per i diversi stadi di sviluppo dello Scaphoideus titanus Le ricerche in merito a questa tematica sono attualmente in corso.
Dobbiamo impegnarci tutti insieme cercando di applicare correttamente principi attivi disponibili coadiuvati da stra tegie agronomiche corrette.
Anche la Denominazione Conegliano Valdobbiadene Prosecco DOCG non è esente da queste problematiche, ma va anche detto che la sinergia tra tecnici del Consorzio e viticoltori si sta dimostrando efficace, a dimostrazione di una maturità anche culturale della Denominazione.
71 70 Conegliano Valdobbiadene Conegliano Valdobbiadene luglio /2022 luglio /2022 IL SOFTWARE per il settore vitivinicolo con CONSULENZA e ASSISTENZA ...E MOLTO ALTRO ANCORA GESTIONALE SPECIFICO PER LE CANTINE REGISTRO TELEMATICO SIAN, e- MVV, e-AD VINIFICAZIONE INTELLIGENTE Tel. 0438 402981 - mail: info@spazioinformatico.com www.spazioinformatico.com A CONEGLIANO DAL 1995 IN STAGIONE IN STAGIONE
Neanide II
Ninfa III
Neanide I Ninfa
V Adulto
Ninfa IV
2 –
–





Via Udine, 39 33095 Rauscedo (PN) ITALIA Tel. +39.0427.948811 www.vivairauscedo.com STUDIOFABBRO.COM PER REALIZZARE VIGNETI AD ALTA SOSTENIBILITÀ AMBIENTALE VCR METTE A DISPOSIZIONE DEI VITICOLTORI 14 VARIETÀ RESISTENTI. PER MAGGIORI INFORMAZIONI CONSULTA IL NOSTRO SITO O CONTATTA LA RETE VENDITA VCR. Noi ci crediamo! Per questo abbiamo scelto la varietà resistente a peronospora e oidio Sauvignon nepiS® Dott. Ermenegildo Giusti — Giusti Wine Minimo rilascio di SO2, H2S ed acetaldeide Vivacità e freschezza nel metodo Charmat I ceppi storici della Champagne Classe ed eleganza nei profumi EC1118 QA23 Rhône 4600 ICV Okay ICV Opale 2.0 CH14 DV10 Lievito inattivo specifico per la protezione dei vini durante le fasi di affinamento e stoccaggio: enfatizza la freschezza e la longevità. Charme Fruity www.lallemandwine.com Via Rossini 14/B • 37060 Castel D’Azzano • VR Tel: +39 045 512 555 • lallemanditalia@lallemand.com Lallemand Italia • L’esp ienza nella presa di spuma


LE NOSTRE FILIALI: Motta di Costabissara (VI) - Adria (RO) - Vedelago (TV) - Candiana (PD) - Torre di Mosto (VE) - Oppeano (VR) - Basiliano (UD) Filiali Kobelco: Bolzano Vicentino (VI) - Monastir (CA) SEDE DI RIFERIMENTO: Via Nazionale, 22 - 31050 Vedelago (TV) - Tel. +39 0423 478544 assistenzavedelago@bassan.com - ricambivedelago@bassan.com - www.bassan.com CONTATTI DIRETTI: Treviso Nord Andrea Serena 333 1065176 Treviso Sud Alberto Jerbonato 335 1005916 AGROPIAVE Via Ormelle 25 - San Polo di Piave (TV) - Tel. 0422 855 012 Fax 0422 855 253 - E-mail: info@agropiave.it www.agropiave.it Filiale di Farra di Soligo: Via Cal della Madonna, 54/A - Farra di Soligo (TV) - Tel. 0438 900 389 E-mail: filialedifarra@agropiave.it Filiale di San Fior: Via Palù, 21 - San Fior (TV) - Tel. 0438 777 967 E-mail: sanfior@agropiave.it Filiale di San Pietro di Feletto: Via Crevada 83/C, Z.I. - San Pietro di Feletto (TV) - Tel. 0438 60342 - E-mail: crevada@agropiave.it per un’Agricoltura sostenibile per un’Agricoltura sostenibile vendita prodotti per la viticoltura, assistenza tecnica, barbatelle, fertilizzanti, analisi fogliari e terreno, prodotti e accessori per impianti vigneto, sementi e mangimi Foto Arcangelo Piai
ENOTURISMO… COME AVVIARLO IN MODO PROFESSIONALE
Hai una cantina con sala degustazione e vuoi sviluppare le nuove potenzialità previste dalla normativa nazionale per l’Enoturismo?


















Vuoi offrire servizi innovativi di conoscenza del territorio tramite il turismo rurale, la fattoria didattica, l’agriturismo?
Possiamo valutare la presenza dei requisiti normativi necessari per l’esercizio dell’attività enoturistica professionale.
Consulenze aziendali di verifica degli aspetti igienico sanitari per le degustazioni e la preparazione degli abbinamenti con prodotti alimentari freddi tipici del territorio. Sviluppo di attività di accoglienza personalizzate e distintive.


www.inventgreen.it

ACCOMPAGNO LATUAAZIENDA AGRICOLA VERSOLA MULTIFUNZIONALITÀ
Conegliano Valdobbiadene luglio /2022
info@inventgreen.it www.inventgreen.it Invent_green Inventgreen Luca
Sede: MOTTA DI LIVENZA (TV) - Filiali: MARENO DI PIAVE (TV) - ZOPPOLA (PN) - PRADAMANO (UD) ALTIVOLE (TV) - BELFIORE (VR) solo MMT - TEL. 0422 860409 - www.fllitonello.eu BREVETTI WAF 1970 - 2020 CINQUANT'ANNI DI PASSIONE Dal 1970 BREVETTI WAF da un semplice disegno, crea, produce ed esporta in tutto il mondo la cultura del “beverage” e della “personalità”, espressione autentica del design Made in Italy. Dalla rassegna del prosecco di Valdobbiadene, alle grandi capitali Europee ed Internazionali, dalle colline toscane ad una cantina di Bordeaux, da un rinomato wine-bar di Milano come in un bistrot di Cortina d'Ampezzo, noterete sempre un oggetto firmato Brevetti waf. Provate
farci caso ... BREVETTI WAF S.r.l. - Via Palazzon 72, 36051 Creazzo (VI) - info@brevettiwaf.it - +39 0444 522058 -
+39 389 1227817
Colussi
a
www.brevettiwaf.it











79 Conegliano Valdobbiadene luglio /2022 78 SRL 1 2 3 6 4 5 + DEPU RAZIONE CANTINE VINICOLE DAL 1982 4.0 READY IMPIANTI + 250 IMPIANTI DI CANTINE VINICOLE REALIZZATI
Abbiamo tolto l’acqua!

CAD-X è il primo climatizzatore che porta le bottiglie in temperatura con pannelli catalitici.




www.wblsystems.com












83 Conegliano Valdobbiadene luglio /2022 82 Conegliano Valdobbiadene Ufficio Agricoltura Agroalimentare e Ambiente Le idee sono il valore che ci differenzia l’uno dagli altri e rendono grande un territorio. Condividi le tue idee con noi per crescere assieme. Banca Prealpi SanBiagio Cresci con noi La presente comunicazione ha natura pubblicitaria con finalità promozionali. Fogli informativi su www.bancaprealpisanbiagio.it Ufficio Agricoltura, Agroalimentare, Ambiente Sede direzionale di Tarzo - Tel. 0438 926362 agricoltura@bancaprealpisanbiagio.it www.bancaprealpisanbiagio.it 50 COMUNI SEGUITI OGNI SETTIMANA 1000 ARTICOLI AL MESE +250.000 VISUALIZZAZIONI AL GIORNO BELLUNESE IL TERRITORIO SIAMO NOI Qdpnews.it è diventata negli anni la testata giornalistica locale più rappresentativa dell'Alta Marca Trevigiana, con una media pari a 250.000 visualizzazioni al giorno: proprio perché è stata la prima a valorizzare l'importanza di queste zone, a partire dalla cronaca fino alle manifestazioni, alla cultura, ai personaggi, alla storia e alle iniziative di qualsiasi genere che in qualche modo interessano o collidono con il territorio.